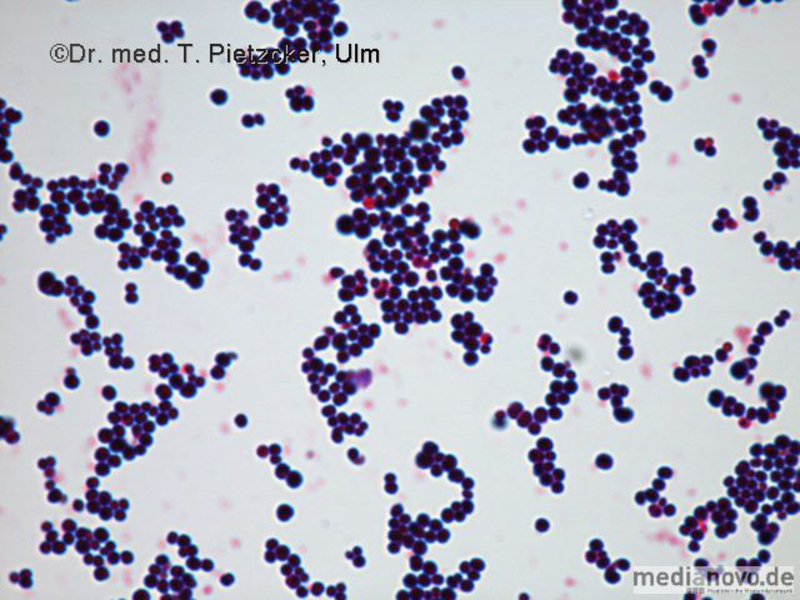
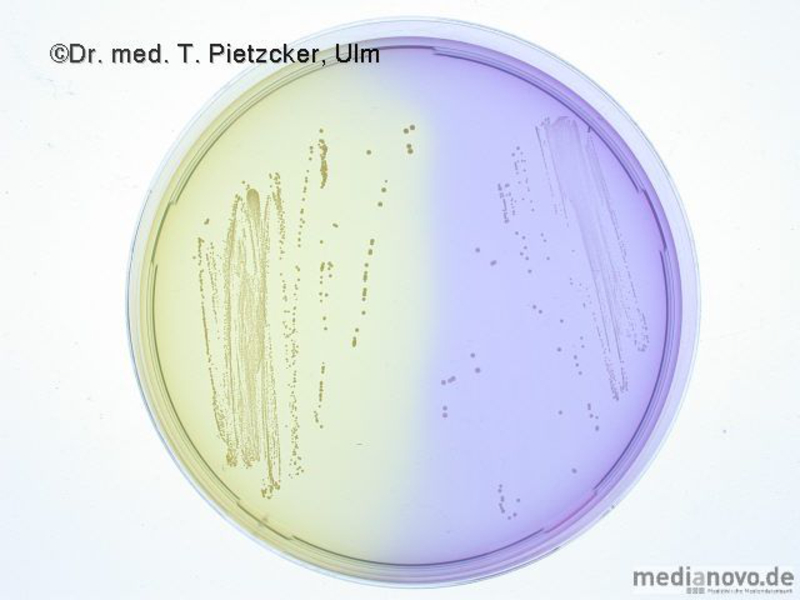

Das Institut für Medizinische Mikrobiologie und Hygiene unterstützt die klinische Diagnose durch den direkten Nachweis von Infektionserregern (Bakterien, Pilze, Protozoen), ihren Antigenen und den gegen sie gerichteten Antikörpern.
Einzelne Untersuchungen, die vor Ort nicht vorgenommen werden können, werden an spezielle, qualifizierte Institute weitergeleitet.
Haben Sie Fragen? Wir sind für Sie da, damit wir Ihnen helfen können.
Kontakt Labor
Telefon +49 731 500-65380
Fax +49 731 500-65304
Sie erreichen uns telefonisch während unserer Öffnungszeiten:
Montag bis Freitag: 07.30 - 17.00 Uhr - Probenannahmeschluss 16:00 Uhr
Wochenende/Feiertag: 07.30 - 12.00 Uhr - Probenannahmeschluss 11:30 Uhr
Außerhalb der Laboröffnungszeiten erreichen Sie in dringenden Fällen
die diensthabende Mikrobiologin bzw. den diensthabenden Mikrobiologen
über die Telefonzentrale des Klinikums.
Allgemeine Informationen und Hinweise für Einsender
Nachfolgend finden Sie Informationen zu den unterschiedlichen Materialien sowie Hinweise zum Materialtransport und zu den Leistungsanforderungen. Ebenso erfahren sie hier mehr über die speziellen Untersuchungs- und Diagnostikverfahren.
Kulturreport
- Kulturreport 11/2025: Multiplex-PCR für urogenitale Mykoplasmen und Ureaplasmen (PDF)
- Kulturreport 04/2025: Multiplex-PCR für bakterielle Erreger respiratorischer Infektionen (PDF)
- Kulturreport 03/2024: Einstellung Chlamydia pneumoniae-Serologie (PDF)
- Kulturreport 07-3/2023: Änderungen in der Blutkulturdiagnostik (PDF)
- Kulturreport 07-2/23: Änderungen in der Diagnostik der Lues (PDF)
- Kulturreport 07/2023: Neuerungen in der Diagnostik ambulant erworbener Meningitis/Encephalitis (PDF)
- Kulturreport 07/2022: Diagnostik Urogenitaler Chlamydien-, Gonokokken- und Trichomonasinfektionen (PDF)
- Kulturreport 01/2021: Pneumokokkenantigen-Schnelltest und Update Pneumoniediagnostik (PDF)
- Kulturreport 04/2019: Änderungen bei der Resistenztestung von Bakterien (PDF)
- Kulturreport 05/2018: Neuerungen Enteritisdiagnostik (PDF)
Online-Anforderung
Alle Untersuchungsanforderungen sollten Online über die Beleglose Laboranforderung erfolgen. Bei Fragen hierzu stehen wir Ihnen unter Telefon 65368 zur Verfügung.
Eine Beispielseite zur Beleglosen Anforderung finden Sie hier.
Nachforderung von Untersuchungen
- Nachforderungen von Untersuchungsanforderungen nach Eintreffen der Probe und des Untersuchungsantrags im Labor sind grundsätzlich möglich. Bitte setzen Sie sich hierzu telefonisch mit dem Anlagelabor (Tel. 65312) in Verbindung.
- Alle diagnostischen Probenmaterialien werden 1 Woche im Kühlschrank im Labor aufbewahrt und stehen somit für Nachforderungen zur Verfügung. Bei der Nachforderung von Untersuchungsanforderungen ist jedoch zu beachten, dass manche Erreger umweltlabil, kälteempfindlich oder wenig sauerstofftolerant sind und ein Nachweis dieser Erreger nach längerer Lagerung der Probe nicht erfolgsversprechend ist. Sofern eine von Ihnen angeforderte Untersuchungsanforderung aufgrund der Wachstumsansprüche der Erreger nicht sinnvoll erscheint, wird Sie der zuständige Laborarzt entsprechend beraten. Bei gezielten Anfragen wenden Sie sich bitte direkt an den für den jeweiligen Laborplatz zuständigen Laborarzt.
- Nachforderungen von serologischen Untersuchungen sind jederzeit möglich, da alle Serumproben über mehrere Jahre tiefgefroren im Labor aufbewahrt werden. Die längere Aufbewahrungsdauer beeinflusst serologische Untersuchungsverfahren in der Regel nicht negativ. Bei Nachforderungen von serologischen Untersuchungen, ggf. auch aus früheren Untersuchungsmaterialien, wenden Sie sich bitte direkt an die Mitarbeiter in der Serologie (Tel. 65327/65376).
Papierformulare zur Leistungsanforderung bei Systemausfall
Wir bitten Sie, die Papierformulare zur Leistungsanforderung nur bei Systemausfällen (IS-H*Med, Konas) zu verwenden.
Die benötigten Formulare können auch lokal auf dem PC vorgehalten werden.
Papierformulare (pdf-File) bitte auf Laser-Drucker ausdrucken.
Die Beschriftung der Patientendaten kann händisch oder mit Etikett erfolgen (sofern Etiketten für die Beschriftung des Entnahmematerials notwendig sind, diese händisch beschriften oder vorgedruckte Etiketten verwenden).
Anforderungsscheine
Unser Labor bietet die Laborleistungen sowohl für privat als auch für gesetzlich versicherte Patienten an.
Für jede Untersuchung von gesetztlich versicherten Patienten benötigen wir einen Überweisungsschein, der der Probe direkt beigelegt werden sollte!
Die Abrechnung der Kosten erfolgt nach der aktuellen Gebührenordnung für Ärzte (GoÄ).
Anforderungsscheine
Anforderungsscheine
Hinweise zum Ausfüllen der Anforderungsscheine
- Bitte senden Sie pro Untersuchungsmaterial einen Anforderungsschein ein!
- Bitte füllen Sie den Schein sorgfältig und vollständig aus. Nur so können wir eine schnelle und effiziente Diagnostik für Sie durchführen!
Anforderungsschein Allgemeine Mikrobiologie
Der Anforderungsschein für die allgemeine Mikrobiologie enthält folgende Bereiche:
Patientendaten/Einsenderdaten: Hier bitte den Nachname, Vorname, Geburtsdatum sowie die Anschrift, Fax/Telefon des Einsenders etc. möglichst genau eintragen.
Diagnostisch relevante Angaben/Verdachtsdiagnose: Hier bitte so genau wie möglich die entsprechenden klinischen Angaben angeben, da die Bearbeitung und Beurteilung der Ergebnisse unter Berücksichtigung der klinischen Angaben erfolgt!
Untersuchungsmaterial: Markieren Sie in diesem Bereich bitte genau eine Materialart! Ist für eine einzelne Materialart kein Markierungsfeld verfügbar, markieren Sie bitte "Sonstiges" und notieren Sie dort die Materialart. Im Feld "Lokalisation" geben Sie bitte evtl. Details zum Entnahmeort ein.
Untersuchungsauftrag: Hier wird unterschieden zwischen einem allgemeinen Untersuchungsauftrag und speziellen Untersuchungsaufträgen.
Mit dem allgemeinen Untersuchungsauftrag "Erregerkultur und Resistenz" werden die üblicherweise vorkommenden Erreger in dem jeweiligen Untersuchungsmaterial erfasst.
Für einige pathogene Erreger, die z. B. spezielle Nährmedien, verlängerte Bebrütungszeiten etc. benötigen, müssen jedoch spezielle Untersuchungsaufträge angefordert werden. Diese speziellen Erreger sind auf dem Anforderungsschein ausdrücklich genannt. Finden Sie einen speziellen Erreger nicht in dieser Liste, setzen Sie sich bitte mit dem zuständigen Laborarzt telefonisch in Verbindung.
Zusatzinformationen Tuberkulose: Bitte den klinischen Verdacht auf eine offene Tuberkulose unbedingt auf dem Anforderungsschein vermerken oder den zuständigen Mikrobiologen (Tel.: 65318/65368) kontaktieren, so dass vorab ein Direktpräparat angefertigt und beurteilt werden kann.
Anforderungsschein Serologie und Molekularbiologie
Der Anforderungsschein für die Serologie und Molekularbiologie enthält folgende Bereiche:
Patientendaten/Einsenderdaten: Hier bitte den Nachname, Vorname, Geburtsdatum sowie die Anschrift, Fax/Telefon des Einsenders etc. möglichst genau eintragen.
Untersuchungsmaterial: Markieren Sie in diesem Bereich bitte genau eine Materialart! Ist für eine einzelne Materialart kein Markierungsfeld verfügbar, markieren Sie bitte "Sonstiges" und notieren Sie dort die Materialart wie auch evtl. Details zum Entnahmeort.
Diagnostisch relevante Angaben/Verdachtsdiagnose: Hier bitte so genau wie möglich die entsprechenden klinischen Angaben angeben, da die Bearbeitung und Beurteilung der Ergebnisse unter Berücksichtigung der klinischen Angaben erfolgt!
Untersuchungsanforderung:
- Bitte markieren Sie hier, ob es sich um eine Erstuntersuchung oder eine Verlaufsuntersuchung handelt. Diese Angaben sind für die Interpretation der Befunde vor großer Wichtigkeit!
- Markieren Sie in diesem Bereich die gewünschten Untersuchungen bzw. nachzuweisenden Erreger.
- Finden Sie einen speziellen Erreger nicht in dieser Liste, setzen Sie sich bitte mit dem zuständigen Laborarzt telefonisch in Verbindung.
Zusatzinformationen: Bitte vermerken Sie zusätzliche für die Diagnostik wichtige Angaben in dem entsprechend markierten Feld.
Nachforderung von Untersuchungen
Nachforderungen von Untersuchungsanforderungen nach Eintreffen der Probe und des Untersuchungsantrags im Labor sind grundsätzlich möglich. Bitte setzen Sie sich hierzu telefonisch mit dem Labor (Tel. 65380) in Verbindung.
Alle diagnostischen Probenmaterialien werden 1 Woche im Kühlschrank im Labor aufbewahrt und stehen somit für Nachforderungen zur Verfügung.
Bei der Nachforderung von Untersuchungsanforderungen ist jedoch zu beachten, dass manche Erreger umweltlabil, kälteempfindlich oder wenig sauerstofftolerant sind und ein Nachweis dieser Erreger nach längerer Lagerung der Probe nicht erfolgsversprechend ist. Sofern eine von Ihnen angeforderte Untersuchungsanforderung aufgrund der Wachstumsansprüche der Erreger nicht sinnvoll erscheint, wird Sie der zuständige Laborarzt entsprechend beraten. Bei gezielten Anfragen wenden Sie sich bitte direkt an den für den jeweiligen Laborplatz zuständigen Laborarzt.
Nachforderungen von serologischen Untersuchungen sind jederzeit möglich, da alle Serumproben über mehrere Jahre tiefgefroren im Labor aufbewahrt werden. Die längere Aufbewahrungsdauer beeinflusst serologische Untersuchungsverfahren in der Regel nicht negativ. Bei Nachforderungen von serologischen Untersuchungen, ggf. auch aus früheren Untersuchungsmaterialien, wenden Sie sich bitte direkt an die Mitarbeiter in der Serologie (Tel. 65327/65376).
Die Standardanforderung "Erregerkultur und Resistenz" umfasst die kulturelle Untersuchung und die Erstellung von Antibiogrammen für obligat und fakultativ pathogene Erreger. Bei primär sterilen Materialien, wie Liquor, Punktaten, Biopsien, umfasst die Anforderung auch die Anfertigung eines mikroskopischen Direktpräparates.
Die eingesetzten Kulturmedien, Anreicherungsverfahren und weiterführenden diagnostischen Verfahren stellen ein dem jeweiligen Untersuchungsmaterial optimal angepasstes Procedere dar, das sich nach den gültigen nationalen und internationalen Standards richtet. Dies schließt materialabhängig auch die Suche nach anaerob wachsenden oder anspruchsvoll wachsenden Keimen mit ein. Beispielsweise werden bei Anforderung "Erreger und Resistenz" aus Hirnabszessmaterialien immer auch Nokardien, Aktinomyzeten und Anaerobier mit erfasst.
Bei anderen Untersuchungsmaterialien, insbesondere solchen, die einem hohen Grad an Kontamination mit physiologischer Flora unterliegen, müssen besondere pathogene Erreger jedoch mittels einer Spezialanforderung vom Einsender gezielt angefordert werden.
Allgemeine Hinweise zur Entnahme und zum Transport von Untersuchungsmaterialien
Eine sachgerechte Entnahme und Transport der Untersuchungsmaterialien trägt wesentlich zur Aussagekraft der im mikrobiologischen Labor erhobenen Untersuchungsergebnisse bei.
Folgende allgemeine Hinweise gelten für (fast) alle Untersuchungsmaterialien:
- Gezielte Probenentnahme unter Vermeidung von Kontaminationen (Normalflora)!
- Temperaturextreme vermeiden!
- Austrocknung der Proben vermeiden!
- Probenentnahme möglichst vor Beginn einer antimikrobiellen Therapie!
- Proben eindeutig beschriften: entweder Online-Aufkleber oder
(bei Anforderungen, die nicht über das Online-System generiert werden) Patientenvor- und nachname, Geburtsdatum, Einsender/Station, Datum der Probenentnahme und Untersuchungsmaterial - Proben möglichst rasch zum mikrobiologischen Labor senden, da bei längerer Lagerung Verschiebungen der Erreger-Quantitäten auftreten können:
- anspruchslose Keime, wie z. B. Staphylokokken und Enterobakterien, vermehren sich
- anspruchsvolle Keime, wie z. B. Haemophilus spp. Pneumokokken und Meningokokken, sterben ab.
- Probe auf schnellstem Weg ins bakteriologische Labor senden, da bereits nach wenigen Stunden Verschiebungen der Erreger-Quantitäten eintreten.
- Probengefäße immer sicher verschließen!
- Beim Transport infektiöser Materialien sind die entsprechenden Transportvorschriften zu beachten! Informationen hierzu erhalten Sie vom Team der Mikrobiologischen Diagnostik.
- Sollten die Proben nicht umgehend zum Labor gesandt werden, Lagerungsbedingungen der Proben beachten.
Probengefäße
Hinweise
• Werden die Abnahme-Vorschriften nicht korrekt eingehalten, besteht das Risiko einer Kontamination der Probe
mit Standort- bzw. Hautflora
• Trotz Einhaltung der Abnahme- und Transportvorschriften besteht ein Risiko, dass empfindliche Keime
nicht kultivierbar sind.
• Es besteht die Möglichkeit, dass im Einzelfall relevante Keime in geringer Keimzahl von Standort-Flora in
großer Keimzahl überwachsen werden und deshalb nicht nachgewiesen werden können.
• Bei Nachweis von Erregern oder DNA kann unter Umständen nicht zwischen einer Besiedelung und einer Infektion
unterschieden werden.
• Einige sehr anspruchsvolle Keime sind mit kulturellen Methoden nicht anzüchtbar.
• Bei molekularbiologischen Untersuchungen können falsch positive Ergebnisse vorkommen.
Bei Verdacht auf eine bakterielle Infektion ohne Erregernachweis ist eine Rücksprache mit dem ärztlichen Personal zur Klärung einer weitergehenden Diagnostik dringend empfohlen.
Untersuchungsmaterialien
Augenabstrich
| Probengefäß: Universal-Abstrichtupfer mit Transportmedium. Für Abstriche bei Neugeborenen und Kindern stehen auch dünnere Abstrichtupfer mit Transportmedium (oranger Deckel) zur Verfügung. |
Abnahme:
|
| Transport: Umgehender Versand der Proben an das Labor bei Raumtemperatur. |
Lagerung: Für die PCR auf Chlamydia trachomatis ist ein Spezialabnahmebesteck für PCR erforderlich. |
| Probengefäß: Universal-Abstrichtupfer mit Transportmedium. |
Abnahme:
|
| Transport: Umgehender Versand der Proben an das Labor bei Raumtemperatur! |
| Lagerung: Ist ein umgehender Versand an das Labor nicht möglich (z. B. bei nächtlicher Entnahme), Probe bei Raumtemperatur bis zum nächsten Tag lagern. |
| Besonderheiten: Bei größeren Bläschen kann auch versucht werden, etwas Flüssigkeit mit einer sterilen Spritze zu aspirieren. |
| Probengefäß: Universal-Abstrichtupfer mit Transportmedium. |
Abnahme:
|
| Transport: Umgehender Versand der Proben an das Labor bei Raumtemperatur. |
| Lagerung: Ist ein umgehender Versand an das Labor nicht möglich (z. B. bei nächtlicher Entnahme), Probe bei Raumtemperatur bis zum nächsten Tag lagern. |
| Besonderheiten: Die Abnahme eines Hautabstrichs ist in der Regel nur sinnvoll bei Vorliegen offener Effloreszenzen der Haut. Eine Kontamination der Untersuchungsprobe mit Bakterien der physiologischen Hautflora ist meist unvermeidlich. |
| Probengefäß: Universal-Abstrichtupfer mit Transportmedium. |
Abnahme:
|
| Transport: Umgehender Versand der Proben an das Labor bei Raumtemperatur. |
| Lagerung: Ist ein umgehender Versand an das Labor nicht möglich (z. B. bei nächtlicher Entnahme), Probe bei Raumtemperatur bis zum nächsten Tag lagern. |
| Besonderheiten: Bitte unbedingt genaue Lokalisation und Kennzeichnung "intraoperativ" angeben, damit eine sachgerechte Interpretation der Befunde erfolgen kann! |
| Probengefäß: Universal-Abstrichtupfer mit Transportmedium. |
Abnahme:
|
| Transport: Umgehender Versand der Proben an das Labor bei Raumtemperatur. |
| Lagerung: Ist ein umgehender Versand an das Labor nicht möglich (z. B. bei nächtlicher Entnahme), Probe bei Raumtemperatur bis zum nächsten Tag lagern. |
| Besonderheiten: Bei Mundabstrichen werden in der Regel Bakterien der physiologischen Mundflora nachgewiesen. Zum Nachweis von Hefen (Candida spp.) bei V. a. Mundsoor ist ein gezielter Untersuchungsauftrag erforderlich! |
| Probengefäß: Universal-Abstrichtupfer mit Transportmedium. Es stehen auch dünnere Abstrichtupfer mit Transportmedium (oranger Deckel) zur Verfügung. |
Abnahme:
|
| Transport: Umgehender Versand der Proben an das Labor bei Raumtemperatur. |
| Lagerung: Ist ein umgehender Versand an das Labor nicht möglich (z. B. bei nächtlicher Entnahme), Probe bei Raumtemperatur bis zum nächsten Tag lagern. |
| Besonderheiten: Bei Nasenabstrichen im Rahmen von Untersuchungen auf MRSA bitte mit einem Tupfer nacheinander in beide Nasenhöhlen streichen! Für die MRSA-PCR im Rahmen des MRSA-Screenings ebenfalls Universal-Abstrichtupfer mit Transportmedium verwenden! |
| Probengefäß: Universal-Abstrichtupfer mit Transportmedium. Es stehen auch dünnere Abstrichtupfer mit Transportmedium (oranger Deckel) zur Verfügung. |
| Abnahme: Bei Gehörgangsabstrichen sollte die Ohrmuschel vorher desinfiziert werden und ggf. Krusten entfernt werden. Mit einem Abstrichtupfer wird dann der Gehörgang rotierend abgestrichen. Bei einem tiefen Gehörgangsabstrich sollte ein Ohrtrichter verwendet werden, um eine Kontamination mit Keimen des Außenohres zu vermeiden. Bei Mittelohrpunktionen und Parazentesen bei geschlossenem Trommelfell zunächst den Gehörgang mit physiologischer NaCl-Lösung säubern. Danach das Trommelfell punktieren bzw. inzidieren und aseptisch etwas Flüssigkeit aspirieren. Bei rupturiertem Trommelfell kann das Untersuchungsmaterial direkt mit einem Tupfer unter Zuhilfenahme eines Spekulums gewonnen werden. |
| Transport: Umgehender Versand der Proben an das Labor bei Raumtemperatur. |
| Lagerung: Ist ein umgehender Versand an das Labor nicht möglich (z. B. bei nächtlicher Entnahme), Probe bei Raumtemperatur bis zum nächsten Tag lagern. |
| Besonderheiten: Bei Ohrabstrichen wird im Labor routinemäßig ein Selektivnährboden zum Nachweis von Schimmelpilzen angelegt. |
| Probengefäß: Universal-Abstrichtupfer mit Transportmedium. |
Abnahme:
|
| Transport: Umgehender Versand der Proben an das Labor bei Raumtemperatur. |
| Lagerung: Ist ein umgehender Versand an das Labor nicht möglich (z. B. bei nächtlicher Entnahme), Probe bei Raumtemperatur bis zum nächsten Tag lagern. |
| Besonderheiten: Bei Verdacht auf Angina Plaut-Vincent sollte zusätzlich "Mikroskopisches Präparat Gram" angefordert werden! |
| Probengefäß: Universal-Abstrichtupfer mit Transportmedium. |
Abnahme:
|
| Transport: Umgehender Versand der Proben an das Labor bei Raumtemperatur. |
| Lagerung: Ist ein umgehender Versand an das Labor nicht möglich (z. B. bei nächtlicher Entnahme), Probe bei Raumtemperatur bis zum nächsten Tag lagern. |
| Besonderheiten: Rektalabstriche werden vorwiegend im Rahmen eines Screenings auf Multiresistente-Erreger (z. B. MRSA, VRE, MRGN) abgenommen. Zur Diagnostik einer Gastroenteritis sind sie nicht geeignet. Rektalabstriche eignen sich auch zum Nachweis einer Chlamydien-Proktitis. Dafür bitte spezielles Abstrichset benutzen. |
| Probengefäß: Universal-Abstrichtupfer mit Transportmedium. |
Abnahme:
|
| Transport: Umgehender Versand der Proben an das Labor bei Raumtemperatur. |
| Lagerung: Ist ein umgehender Versand an das Labor nicht möglich (z. B. bei nächtlicher Entnahme), Probe bei Raumtemperatur bis zum nächsten Tag lagern. |
| Besonderheiten: Bei Verdacht auf Angina Plaut-Vincent sollte zusätzlich "Mikroskopisches Präparat Gram" angefordert werden! |
Probengefäß: Universal-Abstrichtupfer mit Transportmedium |
Abnahme:
|
| Transport: Umgehender Versand der Proben an das Labor bei Raumtemperatur. |
| Lagerung: Ist ein umgehender Versand an das Labor nicht möglich (z. B. bei nächtlicher Entnahme), Probe bei Raumtemperatur bis zum nächsten Tag lagern. |
| Besonderheiten: PCR auf Neisseria gonorrhoeae, Chlamydia trachomatis und Trichomonas vaginalis aus Abstrich oder Urin (bevorzugt Erststrahl-Urin) möglich (Spezialabnahmebesteck für PCR erforderlich). |
| Probengefäß: Universal-Abstrichtupfer mit Transportmedium. |
Abnahme:
|
| Transport: Umgehender Versand der Proben an das Labor bei Raumtemperatur. |
| Lagerung: Ist ein umgehender Versand an das Labor nicht möglich (z. B. bei nächtlicher Entnahme), Probe bei Raumtemperatur bis zum nächsten Tag lagern. |
| Besonderheiten: PCR auf Neisseria gonorrhoeae, Chlamydia trachomatis und Trichomonas vaginalis aus Abstrich oder Urin (bevorzugt Erststrahl-Urin) möglich (Spezialabnahmebesteck für PCR erforderlich). |
| Probengefäß: Universal-Abstrichtupfer mit Transportmedium |
Abnahme:
|
| Transport: Umgehender Versand der Proben an das Labor bei Raumtemperatur. |
| Lagerung: Ist ein umgehender Versand an das Labor nicht möglich (z. B. bei nächtlicher Entnahme), Probe bei Raumtemperatur bis zum nächsten Tag lagern. |
| Besonderheiten: Bei der Untersuchungsanforderung bitte unterscheiden, ob es sich um eine tiefe oder eine oberflächliche Wunde handelt sowie die Wundlokalisation angeben, da diese Angaben Einfluss auf die mikrobiologische Beurteilung der Probe haben! |
| Probengefäß: Universal-Abstrichtupfer mit Transportmedium. |
Abnahme:
|
| Transport: Umgehender Versand der Proben an das Labor bei Raumtemperatur. |
| Lagerung: Ist ein umgehender Versand an das Labor nicht möglich (z. B. bei nächtlicher Entnahme), Probe bei Raumtemperatur bis zum nächsten Tag lagern. |
| Besonderheiten: PCR auf Neisseria gonorrhoeae, Chlamydia trachomatis und Trichomonas vaginalis aus Abstrich oder Urin (bevorzugt Erststrahl-Urin) möglich (Spezialabnahmebesteck für PCR erforderlich). |
| Probengefäß: Steriles Röhrchen mit Schraubdeckel . |
| Abnahme: Das Material wird im Rahmen einer bronchoskopischen Untersuchung gewonnen. Die BAL ist ein repräsentatives Untersuchungsmaterial für Infektionen des Alveolarraumes.
|
| Transport: Umgehender Versand der Proben an das Labor bei Raumtemperatur: |
| Lagerung: Ist ein umgehender Versand an das Labor nicht möglich (z. B. bei nächtlicher Entnahme), BAL bei Raumtemperatur bis zum nächsten Tag lagern. Bei Lagerung im Kühlschrank können empfindliche Bakterien, wie z. B. Haemophilus spp. oder Pneumokokken, absterben! |
| Besonderheiten: BAL werden im Labor nativ und nach Verdünnung quantitativ auf Nährböden angelegt. Daher erfolgt auf dem Befund eine Angabe der Keimzahl in Bakterien pro ml. Jede BAL wird im Labor mikroskopisch mittels Gram-Färbung und Calcofluor-White-Färbung (Spezialfärbung für Pilze) untersucht. Außerdem werden bei jeder BAL Selektivnährmedien für den Nachweis von Legionellen und anaerob wachsende Bakterien routinemäßig mit angelegt. Für die Untersuchung auf Pneumocystis jiroveci ist eine gesonderte Untersuchungsanforderung notwendig! |
| Probengefäß: Steriles Röhrchen mit Schraubdeckel. |
| Abnahme: Das Material wird im Rahmen einer bronchoskopischen Untersuchung gewonnen.
|
| Transport: Umgehender Versand der Proben an das Labor bei Raumtemperatur. |
| Lagerung: Ist ein umgehender Versand an das Labor nicht möglich (z. B. bei nächtlicher Entnahme), Bronchialspülung bei Raumtemperatur bis zum nächsten Tag lagern. Bei Lagerung im Kühlschrank können empfindliche Bakterien, wie z. B. Haemophilus spp. oder Pneumokokken, absterben! |
| Besonderheiten: Hinweis: Bronchialsekret bezeichnet ein Sekret, das im Rahmen einer bronchoskopischen Untersuchung ohne vorherige Spülung mit Kochsalzlösung direkt aus dem Bronchialsystem abgesaugt wird. Wenn Kochsalzlösung in den Bronchialtrakt eingebracht wird, um Sekret absaugen zu können (was in den meisten Fällen notwendig ist), handelt es sich bei der Probe um eine Bronchialspülung. Bronchialsekrete werden im Labor nativ und nach Verdünnung quantitativ auf Nährböden angelegt. Daher erfolgt auf dem Befund eine Angabe der Keimzahl in Bakterien pro ml. |
| Probengefäß: Steriles Röhrchen mit Schraubdeckel . |
| Abnahme: Das Material wird im Rahmen einer bronchoskopischen Untersuchung gewonnen. Die Bronchialspülung ist ein repräsentatives Untersuchungsmaterial für Infektionen des Atemwegsbereiches.
|
| Transport: Umgehender Versand der Proben an das Labor bei Raumtemperatur. |
| Lagerung: Ist ein umgehender Versand an das Labor nicht möglich (z. B. bei nächtlicher Entnahme), Bronchialspülung bei Raumtemperatur bis zum nächsten Tag lagern. Bei Lagerung im Kühlschrank können empfindliche Bakterien, wie z. B. haemophilus spp. oder Pneumokokken, absterben! |
| Besonderheiten: Bronchialspülungen werden im Labor nativ und nach Verdünnung quantitativ auf Nährböden angelegt. Daher erfolgt auf dem Befund eine Angabe der Keimzahl in Bakterien pro ml. |
| Probengefäß: Steriles Probengefäß, z. B. Universal-Probenröhrchen mit Schraubdeckel oder Vanek-Becher. |
Abnahme:
|
| Transport: Umgehender Versand der Proben an das Labor bei Raumtemperatur. |
| Lagerung: Ist ein umgehender Versand an das Labor nicht möglich (z. B. bei nächtlicher Entnahme), Probe bei Raumtemperatur bis zum nächsten Tag lagern. |
| Besonderheiten: Durch die Induktion mit hypertoner Kochsalzlösung soll erreicht werden, dass vermehrt aus Sekret aus den unteren Atemwegen abgehustet wird. Das induzierte Sputum ist insbesondere für die Diagnostik auf Tuberkulose sinnvoll. Bezüglich allgemeiner Hinweise zur Sputum-Diagnostik siehe unter "Sputum". |
| Probengefäß: Steriles Magensaft-Röhrchen mit Natriumphosphatlösung. |
| Abnahme: Hygienische Händedesinfektion und Verwendung von Einmalhandschuhen.
|
| Transport: Möglichst sofort am Abnahmetag bei Raumtemperatur! Der Probentransport muss in sterilen, gegen Auslaufen gesicherten Probenbehältern erfolgen. |
| Lagerung: Ist ein umgehender Versand an das Labor nicht möglich, Probenlagerung im Kühlschrank bei 2-8 °C bis zu 24 Stunden. |
| Besonderheiten: Die Einsendung von Magensaft dient in der Regel der Diangostik einer Tuberkulose. Dazu muss der Magensaft in ein Magensaft-Röhrchen gegeben werden, in dem bereits Natriumphosphatlösung zur Pufferung der Magensäure vorgelegt ist (im Institut für Medizinische Mikrobiologie und HygieneTel.: 65318 erhältlich). Zu achten ist auf die Einsendung bestimmter Mindestmengen an Probenmaterial. Zur Erhöhung der Sensitivität wird die Untersuchung von 3 Proben an 3 aufeinander folgenden Tagen vorgeschlagen. Das NALC-NaOH-Anreicherungsverfahren zur Dekontamination, Homogenisierung und Anreicherung der Proben für den kulturellen, mikroskopischen und molekularbiologischen Nachweis wird von Montag bis Freitag durchgeführt. (Die Proben müssen vor 8 Uhr im Labor eintreffen, ansonsten erfolgt die Bearbeitung am Folgetag). |
| Probengefäß: Steriles Röhrchen mit Schraubdeckel |
Abnahme:
|
| Transport: Umgehender Versand der Proben an das Labor bei Raumtemperatur. |
| Lagerung: Ist ein umgehender Versand an das Labor nicht möglich (z. B. bei nächtlicher Entnahme), Probe im Kühlschrank bei 2-8 °C Raumtemperatur bis zum nächsten Tag lagern. |
Probengefäß: Vanek-Becher |
Abnahme:
Hinweis zur Mykobakteriendiagnostik: Das Abhusten zur Gewinnung einer möglichst großen Probenmenge 2-3mal wiederholen. Bei Untersuchungsanforderung auf atypische Mykobakterien den Mund vor der Sputumgewinnung mit steriler Kochsalzlösung spülen lassen, um eine Kontamination der Probe mit Mykobakterien aus dem Leitungswasser zu vermeiden! |
| Transport: Umgehender Versand der Proben an das Labor bei Raumtemperatur. |
| Lagerung: Ist ein umgehender Versand an das Labor nicht möglich (z. B. bei nächtlicher Entnahme), Probe bei Raumtemperatur bis zum nächsten Tag lagern. Bei ausschließlicher Anforderung auf Mykobakterien sollte das Sputum bei 2-8 °C im Kühlschrank gelagert werden. |
| Besonderheiten: Zum PCR-Nachweis atypischer Pneumonie-Erreger (Mycoplasma pneumoniae, Chlamydia pneumoniae, Legionella pneumophila) ist eine gesonderte Anforderung erforderlich. |
| Probengefäß: Trachealsaugsatz mit Auffangbehälter bzw. steriles Röhrchen mit Schraubdeckel. |
Abnahme:
|
| Transport: Umgehender Versand der Proben an das Labor bei Raumtemperatur. |
| Lagerung: Ist ein umgehender Versand an das Labor nicht möglich (z. B. bei nächtlicher Entnahme), Probe bei Raumtemperatur bis zum nächsten Tag lagern. Bei Lagerung im Kühlschrank können empfindliche Bakterien, wie z. B. Haemophilus spp. oder Pneumokokken, absterben! |
| Probengefäß: Steriles Probengefäß, z. B. Universal-Probenröhrchen mit Schraubdeckel oder Vanek-Becher |
Abnahme:
|
| Transport: Umgehender Versand der Proben an das Labor bei Raumtemperatur. |
| Lagerung: Ist ein umgehender Versand an das Labor nicht möglich (z. B. bei nächtlicher Entnahme), Probe bei Raumtemperatur bis zum nächsten Tag lagern. |
Besonderheiten:
Biopsate aus dem Gastrointestinat-Trakt zur Untersuchung auf Helicobacter pylori in Portagerm pylori Transportmedium geben und die Proben möglichst schnell ins Labor transportieren, da die Erreger sehr empfindlich gegen Umwelteinflüsse sind. |
| Probengefäß: Steriles Probengefäß, z. B. Universal-Probenröhrchen mit Schraubdeckel oder Vanek-Becher |
Abnahme:
|
| Transport: Umgehender Versand der Proben an das Labor bei Raumtemperatur. |
| Lagerung: Ist ein umgehender Versand an das Labor nicht möglich (z. B. bei nächtlicher Entnahme), Probe bei Raumtemperatur bis zum nächsten Tag lagern. |
| Besonderheiten: Bei Verdacht auf Pilzinfektion der Haut ist eine gezielte Untersuchungsanforderung auf Pilze (Hefen, Schimmelpilze und/oder Dermatophyten) erforderlich! |
Probengefäß: Beimpfen gemäß Tabelle in Abhängigkeit des Körpergewichts:
Quellen:
| ||||||||||||||||||||
| Abnahme: Blutkulturen möglichst vor Beginn einer Antibiotika-Therapie abnehmen! Sollten Abnahmen während einer Antibiotika-Therapie erforderlich sein, sollten die Blutkulturen unmittelbar vor Gabe der nächsten Antibiotika-Dosis abgenommen werden.
Die Abnahme von Blutkulturen aus peripheren Venenkathetern, z. B. Viggo, ist nicht indiziert! | ||||||||||||||||||||
| Transport: Blutkulturflaschen umgehend bei Raumtemperatur zum Labor transportieren. | ||||||||||||||||||||
| Lagerung: Ist ein umgehender Versand an das Labor nicht möglich (z. B. bei nächtlicher Entnahme), Probe bei Raumtemperatur bis zum nächsten Tag lagern. Blutkulturflaschen nicht vorbebrüten! | ||||||||||||||||||||
| Besonderheiten: Es sollte stets ein Paar (aerobe/anaerobe) Flasche abgenommen werden, um auch anaerob wachsende Bakterien optimal zu erfassen. Es sollten stets zwei bis drei Blutkulturen entnommen werden, die durch getrennte Punktionen zu gewinnen sind. Bei Verdacht auf akute infektiöse Endokarditis sollten drei Blutkulturen durch drei verschiedene Venenpunktionen innerhalb einer Stunde vor Therapiebeginn abgenommen werden.Bei Verdacht auf subakute Endokarditis (Endokarditis lenta) sollten bis zu 4 Blutkulturen innerhalb von 24 Stunden abgenommen werden. Die Nachweisrate steigt mit der Zahl der abgenommenen Blutkulturen (in der Regel 2-3). Bei Verdacht auf Katheterinfektion ist die simultane Abnahme zentraler und peripherer Blutkulturen (je ein Paar) empfohlen. Außerdem kann bei simultaner Abnahme der Zeitpunkts der Positivmeldung im automatisierten Blutkultur-Gerät ermittelt und die „Differential time to positivity" ermittelt werden. Eine mind. 2 Stunden frühere Positivmeldung der zentralen Blutkultur im Vergleich zur peripheren Kultur spricht für eine Katheterinfektion. |
| Probengefäß: Citrat-Blut-Röhrchen |
Abnahme:
|
| Transport: Umgehender Versand der Proben an das Labor bei Raumtemperatur. |
| Lagerung: Ist ein umgehender Versand an das Labor nicht möglich (z. B. bei nächtlicher Entnahme), Probe im Kühlschrank bis zum nächsten Tag lagern. |
| Besonderheiten: Citrat-Blut wird insbesondere für die Kultur auf Mykobakterien bei Verdacht auf Tuberkulose-Sepsis (z. B. Landouzy-Sepsis) benötigt. |
| Probengefäß: EDTA-Blut-Röhrchen |
Abnahme:
|
| Transport: Umgehender Versand der Proben an das Labor bei Raumtemperatur. |
| Lagerung: Ist ein umgehender Versand an das Labor nicht möglich (z. B. bei nächtlicher Entnahme), Probe bei Raumtemperatur bis zum nächsten Tag lagern. |
Besonderheiten: |
Bitte EDTA-Blut (mikroskopischer Parasitennachweis) bzw. Citrat-Blut (kultureller Erregernachweis z. B. Mykobakterien) abnehmen!
Probengefäß: Vacutainer: InTube-Plasma (enthält 4 QuantiFERON®-TB Gold (QFT) plus Blutentnahmeröhrchen (Nullkontroll-, Tb1 und Tb2-Antigen-, Mitogen-Kontroll-Röhrchen) |
Abnahme:
|
| Transport: Umgehender Versand der Proben an das Labor bei Raumtemperatur. Die Blutproben müssen schnellstmöglich (innerhalb von 16 Stunden nach der Blutentnahme) im Labor eintreffen. |
| Lagerung: Eine Lagerung ist nicht möglich. Keine Einsendung am Wochenende und vor Feiertagen |
Liquor-Drainagespitzen Sonstige Drainage/Katheter-Spitzen sind zur mikrobiologischen Diagnostik ungeeignet. Stattdessen bitte Einsendung von Sekret/Punktat. Probengefäß: |
Abnahme:
|
| Transport: Umgehender Versand der Proben an das Labor bei Raumtemperatur. |
| Lagerung: Ist ein umgehender Versand an das Labor nicht möglich (z. B. bei nächtlicher Entnahme), Probe bei Raumtemperatur bis zum nächsten Tag lagern. |
| Probengefäß: Steriles Transportgefäß, z. B. Vanek-Becher |
Abnahme:
|
| Transport: Umgehender Versand der Proben an das Labor bei Raumtemperatur. |
| Lagerung: Ist ein umgehender Versand an das Labor nicht möglich (z. B. bei nächtlicher Entnahme), Probe bei Raumtemperatur bis zum nächsten Tag lagern. |
| Probengefäß: Steriles Transportgefäß, z. B. Vanek-Becher. |
Abnahme:
|
| Transport: Umgehender Versand der Proben an das Labor bei Raumtemperatur. |
| Lagerung: Ist ein umgehender Versand an das Labor nicht möglich (z. B. bei nächtlicher Entnahme), Probe bei Raumtemperatur bis zum nächsten Tag lagern. |
| Besonderheiten: Bei klinischem Verdacht auf Aktinomykose bitte Untersuchung auf Actinomyces spp. anfordern! |
| Probengefäß: Steriles Transportgefäß, z. B. Vanek-Becher. |
Abnahme:
|
| Transport: Umgehender Versand der Proben an das Labor bei Raumtemperatur. |
| Lagerung: Ist ein umgehender Versand an das Labor nicht möglich (z. B. bei nächtlicher Entnahme), Probe bei Raumtemperatur bis zum nächsten Tag lagern. |
| Besonderheiten: Katheterspitzen werden im Labor gemäß dem Abrollverfahren nach MAKI kultiviert. Koloniezahlen von mehr als 15 Kolonien/Katheterspitze gelten als signifikant für eine Katheterinfektion. |
| Probengefäß: Steriles Transportgefäß, z. B. Vanek-Becher ggf. Kontaktlinsen-Aufbewahrungs-Box |
Abnahme:
|
| Transport: Umgehender Versand der Proben an das Labor bei Raumtemperatur. |
| Lagerung: Ist ein umgehender Versand an das Labor nicht möglich (z. B. bei nächtlicher Entnahme), Probe bei Raumtemperatur bis zum nächsten Tag lagern. |
| Besonderheiten: Bei Verdacht auf Acanthamöben-Infektion: gezielter Untersuchungsauftrag erforderlich. Aufgrund des großen Aufwands und der Seltenheit der Erkrankung strenge Indikationsstellung und Rücksprache mit einem Laborarzt. |
| Probengefäß: Steriles Transportgefäß, z. B. Vanek-Becher. |
Abnahme:
|
| Transport: Umgehender Versand der Proben an das Labor bei Raumtemperatur. |
| Lagerung: Ist ein umgehender Versand an das Labor nicht möglich (z. B. bei nächtlicher Entnahme), Schrittmacherdraht in steriler NaCl über Nacht bei Raumtemperatur lagern. |
siehe unter Rubrik "Abstriche"
siehe unter Rubrik "Biopsien"
| Probengefäß: Steriles Transportgefäß, z. B. Vanek-Becher oder Universal-Transportgefäß mit Schraubdeckel. |
Abnahme:
|
| Transport: Umgehender Versand der Proben an das Labor bei Raumtemperatur. |
| Lagerung: Ist ein umgehender Versand an das Labor nicht möglich (z. B. bei nächtlicher Entnahme), Probe bei Raumtemperatur bis zum nächsten Tag lagern. |
| Besonderheiten: Für die Untersuchung auf Dermatophyten ist eine spezielle Untersuchungsanforderung notwendig, damit ein Selektivmedium beimpft und über mehrere Wochen bebrütet wird! |
| Probengefäß: Steriles Transportgefäß, z. B. Vanek-Becher oder Universal-Transportgefäß mit Schraubdeckel. |
Abnahme:
|
| Transport: Umgehender Versand der Proben an das Labor bei Raumtemperatur. |
| Lagerung: Ist ein umgehender Versand an das Labor nicht möglich (z. B. bei nächtlicher Entnahme), Probe bei Raumtemperatur bis zum nächsten Tag lagern. |
| Besonderheiten: Für die Untersuchung auf Dermatophyten ist eine spezielle Untersuchungsanforderung notwendig, damit ein Selektivmedium beimpft und über mehrere Wochen bebrütet wird! |
| Probengefäß: Steriles Transportgefäß, z. B. Vanek-Becher oder Universal-Transportgefäß mit Schraubdeckel. |
Abnahme:
|
| Transport: Umgehender Versand der Proben an das Labor bei Raumtemperatur. |
| Lagerung: Ist ein umgehender Versand an das Labor nicht möglich (z. B. bei nächtlicher Entnahme), Probe bei Raumtemperatur bis zum nächsten Tag lagern. |
| Besonderheiten: Für die Untersuchung auf Dermatophyten ist eine spezielle Untersuchungsanforderung notwendig, damit ein Selektivmedium beimpft und über mehrere Wochen bebrütet wird! |
Probengefäß: Steriles Röhrchen mit Schraubdeckel |
Abnahme: Lumbale Punktion, nur in Ausnahmefällen subokzipitale Punktion, unter strikter Einhaltung steriler Kautelen! Durchführung der Lumbalpunktion:
Nadel herausziehen, Punktionsstelle mit sterilem Pflaster abdecken, einige Minuten komprimieren, Patient 1 Stunde flach auf Bauch liegen lassen, Sandsack auf die Punktionsstelle legen.
Umgehender Versand der Proben an das Labor bei Raumtemperatur! Lagerung: Ist ein umgehender Versand an das Labor nicht möglich (z. B. bei nächtlicher Entnahme), Liquor bei Raumtemperatur lagern. Besonderheiten: Zusätzlich zur Einsendung von nativem Liquor kann ein Teil (1-2 ml) in eine Blutkulturflasche gegeben werden. Diese dann als Liquor in Blutkultur Flasche anfordern! Der Nachweis von Mcobacterium tuberculosis im Liquor ist nur ausreichend sensitiv bei Einsendung eines hohen Volumens an Liquor, d. h. ca. 3-5 ml Liquor. Bei klinischem Verdacht auf tuberkulöse Meningitis bitte auch PCR anfordern! Bei V. a. Neuroborreliose gepaarte Liquor/Serum-Probe einsenden (siehe Erreger-Info Borrelia burgdorferi). |
| Probengefäß: Je nach Menge z. B. sterile Spritze Universal-Probenröhrchen mit Schraubdeckel Universal-Probenbecher "Vanek-Becher" |
Abnahme:
|
| Transport: Möglichst sofort am Abnahmetag bei Raumtemperatur! |
| Lagerung: Ist ein umgehender Versand an das Labor nicht möglich (z. B. bei nächtlicher Entnahme), Probe bei Raumtemperatur bis zum nächsten Tag lagern. Bei Lagerung im Kühlschrank können empfindliche Bakterien absterben! |
| Besonderheiten: ProbengefäßeZum Nachweis von anaeroben Bakterien Spritze (ohne Lufteinschluss) verwenden! Zum Nachweis von Nokardien und Aktinomyzeten ist eine gezielte Untersuchungsanforderung notwendig. |
| Probengefäß: Je nach Menge z. B. sterile Spritze Universal-Probenröhrchen mit Schraubdeckel Universal-Probenbecher "Vanek-Becher" |
Abnahme:
|
| Transport: Möglichst sofort am Abnahmetag bei Raumtemperatur! |
| Lagerung: Ist ein umgehender Versand an das Labor nicht möglich (z. B. bei nächtlicher Entnahme), Probe bei Raumtemperatur bis zum nächsten Tag lagern. Bei Lagerung im Kühlschrank können empfindliche Bakterien absterben |
| Besonderheiten: Zum Nachweis von anaeroben Bakterien Spritze ohne Lufteinschluss verwenden! Zusätzlich zur Einsendung von Punktat kann ein Teil (ca. 5 ml) in eine Blutkulturflasche gegeben werden. Diese dann als "Punktat-Flasche" kennzeichnen! |
| Probengefäß: sterile Spritze, Universal-Probenröhrchen mit Schraubdeckel Universal-Probenbecher "Vanek-Becher" Blutkulturflasche Kinder |
| Abnahme: Streng aseptisches Vorgehen! Lokalanästhesie nicht immer erforderlich.
|
| Transport: Möglichst sofort am Abnahmetag bei Raumtemperatur! |
| Lagerung: Ist ein umgehender Versand an das Labor nicht möglich (z. B. bei nächtlicher Entnahme), Probe bei Raumtemperatur bis zum nächsten Tag lagern. Bei Lagerung im Kühlschrank können empfindliche Bakterien absterben! |
Besonderheiten: Zusätzlich, oder bei sehr wenig Material (1-3 ml) kann eine Blutkulturflasche Kinder (für geringe Volumen) beimpft werden. Anforderung als Gelenkpunktat in Blutkulturflasche. Zur Diagnostik einer reaktiven Arthritis sind serologische Untersuchungsanforderungen (Arthritis-Screening) erforderlich. |
Probengefäß: |
Abnahme:
|
| Transport: Möglichst sofort am Abnahmetag bei Raumtemperatur! |
| Lagerung: Ist ein umgehender Versand an das Labor nicht möglich (z. B. bei nächtlicher Entnahme), stehen im Operationssaal der Augenklinik Anreicherungsbouillons zur Verfügung. Einen Teil der Probe in die Bouillon geben und die Bouillon sowie den Rest der Probe bei Raumtemperatur bis zum nächsten Tag lagern. Bei Lagerung im Kühlschrank können empfindliche Bakterien absterben! |
Probengefäß: |
Abnahme:
|
| Transport: Umgehender Versand der Proben an das Labor bei Raumtemperatur. |
| Lagerung: Ist ein umgehender Versand an das Labor nicht möglich (z. B. bei nächtlicher Entnahme), Probe bei Raumtemperatur bis zum nächsten Tag lagern. |
Besonderheiten: |
Probengefäß: |
| Abnahme: Streng aseptisches Vorgehen!
|
| Transport: Möglichst sofort am Abnahmetag bei Raumtemperatur! |
| Lagerung: Ist ein umgehender Versand an das Labor nicht möglich (z. B. bei nächtlicher Entnahme), Probe bei Raumtemperatur bis zum nächsten Tag lagern. Bei Lagerung im Kühlschrank können empfindliche Bakterien absterben! |
| Besonderheiten: Zum Nachweis von anaeroben Bakterien Spritze ohne Lufteinschluss verwenden! Zum Nachweis von Mykobakterien ist eine gezielte Untersuchungsanforderung notwendig. |
| Probengefäß: Sterile Spritze, Universal-Probenröhrchen mit Schraubdeckel |
Abnahme:
|
| Transport: Möglichst sofort am Abnahmetag bei Raumtemperatur! |
| Lagerung: Ist ein umgehender Versand an das Labor nicht möglich (z. B. bei nächtlicher Entnahme), Probe bei Raumtemperatur bis zum nächsten Tag lagern. Bei Lagerung im Kühlschrank können empfindliche Bakterien absterben! |
Besonderheiten:
|
| Probengefäß: sterile Spritze Universal-Probenröhrchen mit Schraubdeckel Universal-Probenbecher "Vanek-Becher" |
Abnahme:
|
| Transport: Möglichst sofort am Abnahmetag bei Raumtemperatur! |
| Lagerung: Ist ein umgehender Versand an das Labor nicht möglich (z. B. bei nächtlicher Entnahme), Probe bei Raumtemperatur bis zum nächsten Tag lagern. Bei Lagerung im Kühlschrank können empfindliche Bakterien, wie z. B. Haemophilus spp. oder Pneumokokken, absterben! |
| Besonderheiten: Zum Nachweis von anaeroben Bakterien Spritze ohne Lufteinschluss oder verwenden! Zusätzlich zur Einsendung von Punktat kann ein Teil (ca. 5 ml) in eine Blutkulturflasche gegeben werden. Diese dann als "Punktat-Flasche" kennzeichnen! |
| Probengefäß: Universal-Probenbecher "Vanek-Becher", steriles Stuhlröhrchen mit Löffel |
| Abnahme: Hygienische Händedesinfektion und Verwendung von Einmalhandschuhen.
|
| Transport: Möglichst sofort am Abnahmetag bei Raumtemperatur! Bei längerer Transportdauer Verfälschung der Keimzahlen. |
| Lagerung: Ist ein umgehender Versand an das Labor nicht möglich, Probenlagerung im Kühlschrank bei 2-8 °C bis zu 24 Stunden. |
| Probengefäß: Steriles Röhrchen mit Schraubdeckel. |
| Abnahme: Das Material wird im Rahmen einer bronchoskopischen Untersuchung gewonnen.
|
| Transport: Umgehender Versand der Proben an das Labor bei Raumtemperatur. |
| Lagerung: Ist ein umgehender Versand an das Labor nicht möglich (z. B. bei nächtlicher Entnahme), Bronchialspülung bei Raumtemperatur bis zum nächsten Tag lagern. Bei Lagerung im Kühlschrank können empfindliche Bakterien, wie z. B. Haemophilus spp. oder Pneumokokken, absterben! |
| Besonderheiten: Hinweis: Bronchialsekret bezeichnet ein Sekret, das im Rahmen einer bronchoskopischen Untersuchung ohne vorherige Spülung mit Kochsalzlösung direkt aus dem Bronchialsystem abgesaugt wird. Wenn Kochsalzlösung in den Bronchialtrakt eingebracht wird, um Sekret absaugen zu können (was in den meisten Fällen notwendig ist), handelt es sich bei der Probe um eine Bronchialspülung. Bronchialsekrete werden im Labor nativ und nach Verdünnung quantitativ auf Nährböden angelegt. Daher erfolgt auf dem Befund eine Angabe der Keimzahl in Bakterien pro ml. |
| Probengefäß: Sterile Spritze Universal-Probenröhrchen mit Schraubdeckel Universal-Probenbecher "Vanek-Becher" |
| Abnahme: Hygienische Händedesinfektion und Verwendung von Einmalhandschuhen.
|
| Transport: Möglichst sofort am Abnahmetag bei Raumtemperatur! |
| Lagerung: Ist ein umgehender Versand an das Labor nicht möglich (z. B. bei nächtlicher Entnahme), Probe bei Raumtemperatur bis zum nächsten Tag lagern. Bei Lagerung im Kühlschrank können empfindliche Bakterien absterben! |
| Besonderheiten: Zum Nachweis von anaeroben Bakterien Spritze ohne Lufteinschluss verwenden! |
| Probengefäß: sterile Spritze, Universal-Abstrichtupfer mit Transportmedium. |
| Abnahme: Hygienische Händedesinfektion und Verwendung von Einmalhandschuhen.
|
| Transport: Möglichst sofort am Abnahmetag bei Raumtemperatur! |
| Lagerung: Ist ein umgehender Versand an das Labor nicht möglich, Probenlagerung bei Raumtemperatur bis zu 24 Stunden. |
| Besonderheiten: Die Untersuchung von Drainagesekret kann wertvolle Hinweise auf das Vorliegen einer Infektion im Drainagebereich liefern. Es besteht jedoch immer das Risiko, dass Keime der patienteneigenen Flora, die die (Kunststoff-) Drainage, als Biofilm, besiedeln, nachgewiesen werden. |
| Probengefäß: Universal-Probenbecher "Vanek-Becher". |
Abnahme:
|
| Transport: Möglichst sofort am Abnahmetag bei Raumtemperatur! |
| Lagerung: Ist ein umgehender Versand an das Labor nicht möglich, Probenlagerung bei Raumtemperatur bis zu 24 Stunden. |
Bei V. a. Neisseria gonorrhoeae unverzüglicher Transport ins Labor. |
| Probengefäß: Universal-Probenröhrchen mit Schraubdeckel (blauer Deckel). Universal-Abstrichtupfer mit Transportmedium . |
Abnahme:
|
| Transport: Möglichst sofort am Abnahmetag bei Raumtemperatur! |
| Lagerung: Ist ein umgehender Versand an das Labor nicht möglich (z.B. bei nächtlicher Abnahme), Probenlagerung bei Raumtemperatur bis zum nächsten Morgen. |
| Besonderheiten: Die endoskopische Gewinnung birgt das Risiko einer Kontamination mit Keimen des oberen Respirationstraktes. |
| Probengefäß: Steriles Magensaft-Röhrchen mit Natriumphosphatlösung. |
| Abnahme: Hygienische Händedesinfektion und Verwendung von Einmalhandschuhen.
|
| Transport: Möglichst sofort am Abnahmetag bei Raumtemperatur! Der Probentransport muss in sterilen, gegen Auslaufen gesicherten Probenbehältern erfolgen. |
| Lagerung: Ist ein umgehender Versand an das Labor nicht möglich, Probenlagerung im Kühlschrank bei 2-8 °C bis zu 24 Stunden. |
| Besonderheiten: Die Einsendung von Magensaft dient in der Regel der Diangostik einer Tuberkulose. Dazu muss der Magensaft in ein Magensaft-Röhrchen gegeben werden, in dem bereits Natriumphosphatlösung zur Pufferung der Magensäure vorgelegt ist (im Institut für Medizinische Mikrobiologie und HygieneTel.: 65318 erhältlich). Zu achten ist auf die Einsendung bestimmter Mindestmengen an Probenmaterial. Zur Erhöhung der Sensitivität wird die Untersuchung von 3 Proben an 3 aufeinander folgenden Tagen vorgeschlagen. Das NALC-NaOH-Anreicherungsverfahren zur Dekontamination, Homogenisierung und Anreicherung der Proben für den kulturellen, mikroskopischen und molekularbiologischen Nachweis wird von Montag bis Freitag durchgeführt. (Die Proben müssen vor 8 Uhr im Labor eintreffen, ansonsten erfolgt die Bearbeitung am Folgetag). |
Probengefäß: |
Abnahme:
|
Transport: Möglichst sofort gekühlt am Abnahmetag! |
| Lagerung: Ist ein umgehender Versand an das Labor nicht möglich, Probenlagerung im Kühlschrank bei 2-8 °C bis zu 24 Stunden. |
| Probengefäß: Universal-Probenbecher "Vanek-Becher", Universal-Abstrichtupfer mit Transportmedium Es stehen auch dünnere Abstrichtupfer mit Transportmedium (oranger Deckel) zur Verfügung. |
Abnahme:
|
| Transport: Möglichst sofort am Abnahmetag bei Raumtemperatur! |
| Lagerung: Ist ein umgehender Versand an das Labor nicht möglich, Probenlagerung bei Raumtemperatur bis zu 24 Stunden. |
Besonderheiten: |
| Probengefäß: Sterile Spritze Universal-Probenröhrchen mit Schraubdeckel, |
Abnahme:
|
| Transport: Um ein Absterben empfindlicher Erreger (z. B. Pneumokokken, Anaerobier) zu vermeiden, sollten der Probentransport und die Materialanlage so rasch wie möglich nach Abnahme des Sekretes erfolgen. Bei Transportzeiten >24 Stunden ist die Aussagekraft des resultierenden mikrobiologischen Befundes eingeschränkt. |
| Lagerung: Ist ein umgehender Versand an das Labor nicht möglich, Probenlagerung bei Raumtemperatur bis zu 24 Stunden. |
| Besonderheiten: Für eine adäquate mikrobiologische Untersuchung von Sinussekreten wird Material benötigt, das entweder durch eine Punktion der NNH bzw. intraoperativ während einer operativen Eröffnung der NNH gewonnen wird. Offen durch die Nase abgelaufene NNH-Spülflüssigkeiten oder Nasenabstriche sind zur Sinusitisdiagnostik nicht geeignet, da sie mit physiologischer Nasenflora kontaminiert sind. |
| Probengefäß: Trachealsaugsatz mit Auffangbehälter bzw. steriles Röhrchen mit Schraubdeckel. |
Abnahme:
|
| Transport: Umgehender Versand der Proben an das Labor bei Raumtemperatur. |
| Lagerung: Ist ein umgehender Versand an das Labor nicht möglich (z. B. bei nächtlicher Entnahme), Probe bei Raumtemperatur bis zum nächsten Tag lagern. Bei Lagerung im Kühlschrank können empfindliche Bakterien, wie z. B. Haemophilus spp. oder Pneumokokken, absterben! |
| Probengefäß: Universal-Abstrichtupfer mit Transportmedium Es stehen auch dünnere Abstrichtupfer mit Transportmedium (oranger Deckel) zur Verfügung. |
Abnahme:
|
| Transport: Möglichst sofort am Abnahmetag bei Raumtemperatur! |
| Lagerung: Ist ein umgehender Versand an das Labor nicht möglich, Probenlagerung bei Raumtemperatur bis zu 24 Stunden. |
Besonderheiten: Bei V. a. Neisseria gonorrhoeaeunverzüglicher Transport ins Labor. ZPCR auf Neisseria gonorrhoeae, Chlamydia trachomatis und Trichomonas vaginalis aus Abstrich oder Urin (bevorzugt Erststrahl-Urin) möglich (Spezialabnahmebesteck für PCR erforderlich).
|
| Probengefäß: Serum-Röhrchen. |
| Abnahme: Hygienische Händedesinfektion und Verwendung von Einmalhandschuhen. Punktion meist in der Ellenbeuge.
|
| Transport: Möglichst sofort am Abnahmetag bei Raumtemperatur! |
| Lagerung: Ist ein umgehender Versand an das Labor nicht möglich (z. B. bei nächtlicher Entnahme), Probenlagerung bei Raumtemperatur bis zum nächsten Morgen. |
| Probengefäß: Universal-Probenröhrchen mit Schraubdeckel (blauer Deckel). Universal-Probenbecher "Vanek-Becher". |
| Abnahme: Hygienische Händedesinfektion und Verwendung von Einmalhandschuhen.
|
| Transport: Möglichst sofort am Abnahmetag innerhalb einer Stunde bei Raumtemperatur! |
| Lagerung: Ist ein umgehender Versand an das Labor nicht möglich, Probenlagerung bei Raumtemperatur. |
| Besonderheiten: Duodenalsekret sollte nativ bzw. als Sediment auf Giardia duodenalis (vormals Lamblien) untersucht werden, wenn bei negativen Stuhlproben anhaltender Infektionsverdacht besteht. |
| Probengefäß: Steriles Stuhlröhrchen mit Löffel |
| Abnahme: Hygienische Händedesinfektion und Verwendung von Einmalhandschuhen.
|
Transport: Der Probentransport sollte bei Raumtemperatur (2°C-25°C) noch am Tag der Probenentnahme erfolgen. Sollte in Ausnahmefällen oder am Wochenende die Materialverarbeitung nicht innerhalb von 24 Stunden nach Probenahme möglich sein, erfolgt die Lagerung des Materials im Kühlschrank bei 2-8 °C. |
| Lagerung: Ist ein umgehender Versand an das Labor nicht möglich (z. B. bei nächtlicher Entnahme), Probenlagerung im Kühlschrank bei 2-8 °C bis zu 24 Stunden. |
Besonderheiten:
|
| Probengefäß: Universal-Probenbecher "Vanek-Becher", Borsäure-Röhrchen |
| Abnahme: Suprapubische Blasenpunktion z.B. im Rahmen einer Cystofixanlage unter strikter Einhaltung steriler Kautelen!
|
| Probengefäß: Universal-Probenbecher "Vanek-Becher", Borsäure-Röhrchen, |
Abnahme:
10 ml des Urins in ein steriles Borsäureröhrchen überführen. |
| Transport: Möglichst sofort am Abnahmetag bei Raumtemperatur! |
| Lagerung: Lagerung von Urin im Borsäure-Röhrchen bis zu 24 Stunden bei Raumtemperatur. |
| Besonderheiten: Bei der Abnahme von Dauerkatheterurin ist unbedingt darauf zu achten, dass der Urin frisch gewonnen wird. Es sollte kein Urin abgenommen werden, der sich bereits einige Zeit im Beutel befand, da im Urinbeutel eine Vermehrung der Keime stattfindet! |
| Probengefäß: Universal-Probenbecher (Vanek-Becher) Borsäureröhrchen |
| Abnahme: Es gibt verschiedene Kathetersysteme. In der Regel werden Größen von 14-18 Charierre verwendet.
|
| Transport: Möglichst sofort am Abnahmetag bei Raumtemperatur! |
| Lagerung: Lagerung des Urins im Borsäure-Röhrchen bis zu 24 Stunden bei Raumtemperatur. |
Besonderheiten: |
Probengefäß: Borsäure-Röhrchen Universal-Probenbecher "Vanek-Becher" |
Abnahme:
|
| Transport: Möglichst sofort bei Raumtemperatur! |
| Lagerung: Probenlagerung von Urin im Borsäure-Röhrchen bis zu 24 Stunden bei Raumtemperatur. |
Besonderheiten:
|
| Probengefäß: Borsäure-Röhrchen Universal-Probenbecher "Vanek-Becher" |
Abnahme:
|
| Transport: Möglichst sofort am Abnahmetag bei Raumtemperatur! |
| Lagerung: Lagerung von Urin im Borsäure-Röhrchen bis zu 24 Stunden bei Raumtemperatur. |
| Besonderheiten: Bei Leukozyturie ohne signifikante Bakteriurie ist an untypische Erreger, wie z.B. Mycobacterium tuberculosis, zu denken. |
Probengefäß: |
Abnahme:
|
| Transport: Möglichst sofort am Abnahmetag bei Raumtemperatur! |
| Lagerung: Lagerung von Urin im Borsäure-Röhrchen bis zu 24 Stunden bei Raumtemperatur. |
Besonderheiten: PCR auf Neisseria gonorrhoeae, Chlamydia trachomatis und Trichomonas vaginalis aus Abstrich oder Urin (bevorzugt Erststrahl-Urin) möglich (Spezialabnahmebesteck für PCR erforderlich). |
| Probengefäß: Universal-Probenbecher "Vanek-Becher" Borsäureröhrchen |
| Abnahme: Gewinnung am besten am Morgen, vor dem Wasserlassen oder 4 Std. nach der letzten Miktion:
|
| Transport: Möglichst sofort am Abnahmetag bei Raumtemperatur! |
Lagerung: Lagerung von Urin im Borsäure-Röhrchen bis zu 24 Stunden bei Raumtemperatur. |
Besonderheiten: Zum Nachweis von Schistosoma haematobium frisch gewonnener Einzelurin (Aktivitätsurin) oder 24-Stunden-Sammelurin in Frage. Es sollten mindestens 10 ml Urin gewonnen werden. Die besten Ergebnisse werden erzielt, wenn der Urin zwischen 12 und 14 Uhr und nach größerer körperlicher Anstrengung gewonnen wurde (Patienten Treppen steigen lassen). PCR auf Neisseria gonorrhoeae, Chlamydia trachomatis und Trichomonas vaginalis aus Abstrich oder Urin (bevorzugt Erststrahl-Urin) möglich (Spezialabnahmebesteck für PCR erforderlich) |
| Probengefäß: Universal-Probenbecher "Vanek-Becher", oder Uricult |
| Abnahme: Gewinnung am besten am Morgen
|
| Transport: Möglichst sofort am Abnahmetag bei Raumtemperatur! |
| Lagerung: Ist ein umgehender Versand an das Labor nicht möglich (z. B. bei nächtlicher Entnahme) Lagerung des Urikults bei Raumtemperatur. |
| Besonderheiten: Bei Leukozyturie ohne signifikante Bakteriurie ist an eine Urethritis oder an untypische Erreger, wie z. B. Mycobacterium tuberculosis, zu denken. |
Leistungsverzeichnis nach Infektionskrankheiten
| Inzidenz und Erregerspektrum: Die Brucellose ist eine Anthropozoonose. Brucellen finden sich insbesondere im Urogenitaltrakt von Rindern (B. abortus), Schweinen (B. suis), Ziegen und Schafen (B. melitensis). Dort verursachen sie eine Entzündung der Plazenta mit der Folge Abort und Sterilität. Es kann sich eine chronische Infektion mit lebenslanger Persistenz der Erreger mit langdauernder Ausscheidung in der Milch entwickeln. Weltweit werden jährlich etwa 500.000 Brucelleninfektionen beim Menschen erfasst. Infektionen durch B. abortus sind in Deutschland dank effektiver Kontrollmaßnahmen nahezu verschwunden. In Deutschland kommt es im Wesentlichen durch Genuss von importierten und nicht-pasteurisierten Milchprodukten aus Ländern, in denen die Brucellose noch endemisch (Mittelmeerraum) ist, zu Infektionen. Meist handelt es sich um "importierte" Erkrankungen von Gastarbeitern und Urlaubsreisenden. Die endemische Brucellose findet sich expositionsbedingt vorwiegend bei Landwirten, Metzgern, Veterinären, Molkerei- und Schlachthausarbeitern. Brucellen werden von infizierten Tieren mit der Milch (wichtigster Übertragungsweg für den Menschen), dem Urin, der Fäzes oder mit der Plazenta bei der Geburt oder bei Abort ausgeschieden. Eine Übertragung von Mensch zu Mensch findet nicht statt. Die Inkubationszeit beträgt 1 Woche bis mehrere Monate. Nach Prodromalsymptomen wie Müdigkeit, mäßigem Fieber, Kopf- und Gliederschmerzen kommt es bei Infektionen mit B. melitensis zu einem raschen Temperaturanstieg bis 40 °C (typisch ist ein undulierender Fieberverlauf mit profuser Schweißneigung). Im Stadium der Organmanifestation kommt es zu Hepatosplenomegalie, Ikterus und Lymphadenopathie. Die Symptome können über Monate hinweg rezidivierend auftreten. Relativ häufige Komplikationen sind Arthritis und Spondylitis (Befall der Brust- und Lendenwirbel), Manifestationen am Urogenitaltrakt (Orchitis, Epididymitis), neurologische Ausfälle (periphere Neuritiden, Meningoenzephalitiden) und Manifestationen am Herzen. Die Letalität der unbehandelten Erkrankung liegt bei ca. 2 %. Humane Infektionen mit B. abortus verlaufen häufig mild oder inapparent. |
| Untersuchungsmaterial: Blutkulturen Serum Biopsate (Lymphknoten) Punktate (Knochenmark) |
| Basisdiagnostik: Es erfolgt ein kultureller und serologischer Erregernachweis. Für die Untersuchung auf Brucella spp. sollte bei klinischem Verdacht eine gezielte Untersuchungsanforderung erfolgen, da die Blutkulturen und andere Nährmedien länger als üblich bebrütet werden müssen! |
| Weiterführende Diagnostik: Es gibt kein Standardverfahren oder spezielle Grenzwerte zur Empfindlichkeitsprüfung von Brucella spp.. Daher und aufgrund der hohen Infektiosität des Erregers wird auf eine Resistenzprüfung in unserem Labor verzichtet. |
| Sonstiges B. melitensis wird gemäß Biostoffverordnung als Erreger der Sicherheitsstufe 3 eingestuft. Aufgrund der Gefahr von Laborinfektionen bitte bei klinischem Hinweis auf Brucellose (Nahrungsmittel,- Beruf-, Reiseanamnese) unbedingt entsprechenden Vermerk auf der Anforderung geben! Meldepflicht bei Erkrankung und Tod. |
| Inzidenz und Erregerspektrum: Die Malaria ist weltweit in den tropischen Ländern verbreitet, wobei sich die Verbreitungsgebiete der einzelnen Malaria-Erreger unterscheiden. Jährlich sterben etwa 0,5 bis 2 Millionen Menschen an Malaria, 80-90 % davon im tropischen Afrika. Pro Jahr werden ca. 1000 Fälle nach Deutschland importiert, von denen ca. 30 tödlich enden. Klinisch verläuft die Malaria als fieberhafte Erkrankung mit Schüttelfrost. Sie hat eine Inkubationszeit von mind. 5 Tagen. Die Malaria tropica verläuft häufig sehr schwer und geht oft mit Komplikationen wie Anämie, Ikterus, Nierenversagen, ZNS-Beteiligung und Lungenödem einher. Die Malaria tertiana und Malaria quartana stellen mildere Erkrankungen dar, die hauptsächlich durch rezidivierende Fieberschübe gekennzeichnet sind. Bei der Malaria tertiana können die Erreger über Jahrzehnte in der Leber persistieren und zu häufig wiederkehrenden Fieberschüben führen. Alle Malaria-Formen werden durch Protozoen der Gattung Plasmodium hervorgerufen. Es gibt vier humanpathogene Spezies: Plasmodium falciparum (Verursacher der Malaria tropica), P. malariae (Verursacher der Malaria quartana), P. ovale und P. vivax (Verursacher der Malaria tertiana). In Südostasien kann in seltenen Fällen eine Malaria durch Plasmodium knowlesi auftreten. Die Plasmodien werden über den Stich infizierter Mücken der Gattung Anopheles auf den Menschen übertragen. Sie vermehren sich im Menschen zunächst in der Leber und später nach Freisetzung aus der Leber in den Erythrozyten. In den Erythrozyten bilden sie Ringformen. Diese entwickeln sich über Trophozoiten zu mehrkernigen Schizonten, die durch Platzen der Erythrozyten (dies führt klinisch zur Anämie) wieder freigesetzt werden. Sie entwickeln sich im Blut weiter zu geschlechtlichen Formen (Gametozyten) oder können neue Erythrozyten befallen. Bei einem Mückenstich werden die Gametozyten erneut von Anopheles-Mücken aufgenommen, und durch Weiterentwicklung im Darm der Mücke schließt sich der Kreislauf. Die verschiedenen Plasmodien-Arten können morphologisch im Blutausstrich unterschieden werden. Von besonderer Wichtigkeit ist es, P. falciparum zu erkennen, da die unverzügliche Therapie der Malaria tropica lebensrettend sein kann. |
Untersuchungsmaterial: |
Basisdiagnostik: Es erfolgt außerdem immer der mikroskopische Nachweis der Plasmodien im Blutausstrich und im Dicken Tropfen (nach Giemsa-Färbung). Dabei erfolgt auch eine Differenzierung der verschiedenen Plasmodien-Arten, sowie bei Malaria tropica eine Quantifizierung der Parasitämie. |
Sonstiges: Außerhalb der Laboröffnungszeiten erfolgt der Schnelltest in der Klinischen Chemie. Für den mikroskopischen Nachweis wird das Untersuchungsmaterial zeitnah (am Folgetag) an die Mikrobiologie weitergeleitet. |
Inzidenz und Erregerspektrum Die Sepsis ist definiert als eine systemisch-entzündliche Reaktion auf eine Infektion, wobei in der Regel von einem Herd aus konstant oder periodisch Mikroorganismen in die Blutbahn eindringen und Absiedelungen oder Schädigungen an anderen Organen verursachen. | ||||||||||||||||||||
Untersuchungsmaterial: Empfehlungen zu Abnahme von Blutkulturen in Abhängigkeit des Körpergewichts:
Paed-Flasche: Spezielle Flasche für Kleinkinder Quellen:
Der Transport der Blutkulturflaschen in das Labor sollte innerhalb von 24 Stunden erfolgen.
Bei fehlenden Hinweisen auf einen Infektionsherd sollten aufgrund der Häufigkeit von Harnwegsinfektionen in jedem Fall Urin und weiterhin, falls möglich, Sputum untersucht werden. Untersuchungsmaterial aus primär sterilen Körperkompartimenten (z. B. Punktate) können zur Diagnostik in eine Blutkulturflasche beimpft werden; sonstige Abstriche, Drainagen und Sekrete aus dem Respirations- oder Gastrointestinaltrakt sollten nativ in einem entsprechenden Transportgefäß schnellstmöglich ins Labor versandt werden. | ||||||||||||||||||||
| Basisdiagnostik: Im Rahmen der Basisdiagnostik genügt die Anforderung „Erreger und Resistenz“ auf dem Anforderungsschein. Die Blutkulturen werden im automatisierten Bebrütungsgerät 5 Tage bebrütet. Bei positivem Signal des Gerätes werden die gewachsenen Bakterien zunächst mikroskopisch differenziert und dann für die Speziesdifferenzierung und Resistenztestung auf Anreicherungs- und Selektivnährböden angezüchtet. Eine Antibiotika-Resistenztestung liegt in der Regel spätestens 48 Stunden nach Mitteilung des mikroskopischen Befundes vor. Bei Wachstum schnell wachsender Keime wie Enterobakterien und S. aureus liegt eine Resistenztestung in der Regel bereits nach 24 Stunden vor. Bestehen in der Anamnese oder Klinik bereits Hinweise auf eine Infektion mit schwer anzüchtbaren, sehr langsam wachsenden Bakterien (z. B. Brucellen), so sollte dieses auf dem Anforderungsschein vermerkt werden, damit die Blutkulturen länger als 5 Tage bebrütet werden und ggf. Spezialnährböden für die Erreger-Anzucht verwendet werden. Die Untersuchung von Materialien aus Sepsisherden sollte nach den üblichen diagnostischen Maßgaben erfolgen. Bei Urinen, Punktaten, Trachealsekreten etc. genügt in der Regel die Anforderung „Erreger und Resistenz“. | ||||||||||||||||||||
| Weiterführende Diagnostik: Kann in der üblichen Blutkultur- und Herduntersuchung kein Sepsis-Erreger isoliert werden, so sollten, je nach Anamnese und klinischem Bild, auch seltenere oder nur unter speziellen Bedingungen anzüchtbare Keime in die Diagnostik mit einbezogen werden. Dies betrifft insbesondere Patienten mit Immunsuppression und einer Auslands- bzw. Tropen-Anamnese. Bei Verdacht auf eine durch Pilze hervorgerufene Sepsis kann neben der Kulturanlage auf speziellen Pilz-Kulturplatten auch ein Antigennachweis im Serum für Candida, Aspergillus und Cryptococcus durchgeführt werden. Bei diesen Antigennachweisen ist jedoch zu beachten, dass die kommerziell erhältlichen Teste z. T. nur eine Sensitivität von 60-90 % aufweisen und somit ein negativer Test keinesfalls eine Fungämie ausschließt. Ein Antigen-Test aus dem Urin ist weiterhin empfohlen zur Abklärung einer durch Legionellen oder Pneumokokken induzierten Sepsis. Bei Verdacht auf eine durch Mycobacterium tuberculosis-Komplex verursachte sog. Landouzy-Sepsis, Kulturanlage aus Citrat-Blut. Bei positivem mikroskopischem Präparat in respiratorischen Sekreten kann auch ein Nukleinsäure-Nachweis mittels PCR versucht werden. Bei vorhergehenden Tropenaufenthalten sollte auch an septisch-verlaufende Erkrankungen wie Malaria (Dicken Tropfen und Ausstrich anfordern), Typhus (Blutkultur) etc. gedacht werden. | ||||||||||||||||||||
| Sonstiges: Die Interpretation von Blutkultur-Ergebnissen im klinischen Kontext spielt zur Klärung der Frage einer signifikanten Bakteriämie eine besondere Rolle. Auf eine Kontamination der Blutkultur bei der Abnahme deutet insbesondere hin:
| ||||||||||||||||||||
Tabelle 1: Erregerspektrum in Abhängigkeit von der Sepsisform (Beispiele):
| ||||||||||||||||||||
|
Inzidenz und Erregerspektrum: Campylobacter Salmonellen Yersinien Shigellen. E. coli (z.B. EHEC) Weitere wichtige Enteritis-Erreger und ihre Charakteristika sind im Folgenden aufgeführt (siehe Tabelle). Die häufigste Ursache einer nosokomialen bzw. antibiotika-assoziierten Colitis ist Clostridioides difficile (früher Clostridium difficile). | |||||||||||||||||||||||||||||||||
| Untersuchungsmaterial: Die eingesandte Stuhlmenge sollte etwa haselnussgroß sein. Parasiten sind nicht gleichmäßig im Darm verteilt, sondern sitzen in Nestern in den Zottenzwischenräumen oder in Divertikeln des Dickdarmes. Es ist daher ratsam, vor der Probennahme mit dem Entnahmelöffel den Stuhl durchzurühren. Danach sollte die Stuhlprobe von verschiedenen Stellen genommen werden. | |||||||||||||||||||||||||||||||||
Basisdiagnostik Anforderung bakterielle Gastroenteritiserreger Es wird eine multiplex PCR durchgeführt, welche folgende Erreger beinhaltet:
Bei Eingang bis 10:30 Uhr erfolgt die Untersuchung am selben Tag, bei positivem Ergebnis wird die Kultur mit Resistenztestung (außer EHEC) angeschlossen. | |||||||||||||||||||||||||||||||||
Weiterführende Diagnostik:
|
Inzidenz und Erregerspektrum:
S. aureus, KNS, Streptokokken, Pseudomonaden, Acinetobacter und Enterobakterien, Schimmelpilze, Propionibacterium (bei protrahiertem Verlauf)
Bacillus spp., Clostridien, KNS, gramnegative Stäbchen, Schimmelpilze (Verletzungen mit Pflanzenmaterial), Streptokokken (insbes. bei Kindern).
S. aureus, Candida spp. Aspergillus spp. Enterobakterien, Pneumokokken, Haemophilus spp., Neisseria meningitidis, Mucorales (fortgeleitet aus HNO-Bereich). |
Materialabnahme und Versand:
|
| Basisdiagnostik: Erreger und Resistenz |
| Gezielte Diagnostik: Bei klinischem Hinweis auf ausgefallene Mikroorganismen (Actinomyzeten, Mykobakterien, Aspergillus spp. und andere hyaline Schimmelpilze, Mucor spp. und andere Zygomyzeten) gezielte Anforderung. |
Befundmitteilung:
|
| Inzidenz und Erregerspektrum: Eine Konjunktivitis ist eine auf infektiöser, physikalischer oder allergischer Ursache beruhende Entzündung der Bindehaut. Typische bakterielle Erreger einer Konjunktivitis mit und ohne Blepharitis sowie einer Dakryoadenitis und -zystitis sind: S. aureus, ß-hämolysierende Streptokokken, S. pneumoniae, H. influenzae, M. catarrhalis, P. aeruginosa, verschiedene Enterobakteriazeen und Chlamydia trachomatis. Selten kommen auch Neisseria gonorrhoeae, N. meningitidis, S. epidermidis, L. monocytogenes, Actinomyces spp., M. tuberculosis und andere vor. Bei der Keratitis handelt es sich um eine meist durch lokale Verletzung und konsekutiver Infektion ausgelöste Entzündung der Hornhaut. Das Erregerspektrum schließt zusätzlich v. a. auch Pilze (Candida, Aspergillus) ein. Als weitere Erreger sind Viren (meist Adenoviren, HSV, VZV, selten auch CMV, Masern- und Rötelnvirus) sowie seltener auch Protozoen (Mikrosporidien, Acanthamoeben) in Betracht zu ziehen. Untersuchungen auf Acanthamoeba sind i. d. R. nur sinnvoll bei Kontaktlinsen-Keratitis, nicht jedoch bei unspezifischen Augenentzündungen. |
| Untersuchungsmaterial: Augenabstrich Hornhautabstrich Hornhautgeschabsel |
| Basisdiagnostik: Es erfolgt ein kultureller Erregernachweis. Bei V. a. langsam wachsenden und/oder seltenen Erregern (z.B. Actinomyces spp., Mykobakterien, Pilze) sollte eine gezielte Untersuchungsanforderung erfolgen, da die Nährmedien länger als üblich bebrütet werden müssen! |
| Weiterführende Diagnostik: Die virologische Diagnostik (z. B. bei V.a. Herpes-simplex-Keratitis, Zoster ophthalmicus, Adenoviren bei Keratoconjunktivitis epidemica) erfolgt in der Abteilung Virologie. Zum Nachweis oder Ausschluss einer Infektion durch Toxoplasma gondii oder Toxocara canis (externe Untersuchung) sind serologische Nachweisverfahren erforderlich. |
Sonstiges: Zum DNA-Nachweis von N. gonorrhoeae und/oder Chlamydia trachomatis mittels PCR ist ein spezielles Abstrich-Set erforderlich, das in der Klinikumsapotheke bestellt werden kann. Auf Grund der Seltenheit einer Acanthamöben-Keratitis sollte vor der Acanthamöben-Diagnostik eine bakterielle oder virale Infektion ausgeschlossen sein. |
| Inzidenz und Erregerspektrum: Die häufigsten Erreger bei Katheter-assoziierten Infektionen sind KNS (koagulase negative Staphylokokken),S. aureus, Enterokokken, gramnegative Stäbchenbakterien (z. B. E. coli) und Candida spp.. Seltenere Erreger (z. B. atypische Mykobakterien oder Anaerobier) findet man zunehmend bei Immunsupprimierten. Die Diagnose "Katheter-assoziierte Sepsis" erfordert neben dem Erregernachweis an der Katheterspitze und einer Blutkultur auch eine klinisch manifeste Infektionssymptomatik (Fieber, Schüttelfrost oder Hypotension). Ansonsten spricht man auch nur von einer Besiedlung/Kolonisation des Katheters. Bei den Gefäßkathetern unterscheidet man solche für den kurzzeitigen (Ein- oder Mehrlumige Silikon- oder Polyurethankatheter) und solche für den längerfristigen Einsatz (meist chirurgisch implantierte, getunnelte, wie Port, Hickmankatheter). Kurzzeitkatheter werden zumeist von Hautmikroorganismen, die entlang der Einstichstelle an der Außenseite des Katheters zur Spitze entlang wachsen besiedelt, während bei Langzeitkathetern eher von einer primären Kontamination des Katheteransatzstücks ausgegangen wird. Bei allen Patienten mit Gefäßkathetern, insbesondere aber bei chirurgisch implantierten Kathetern oder bei Patienten, bei denen die Entfernung des Katheters fast unmöglich ist (z. B. Gerinnungsprobleme bei KMT-Patienten, keine weiteren Gefäßzugänge), kann die Bestimmung der DTTP (differential time to positivity) Aufschluss geben, ob eine Katheterassoziierte Infektion wahrscheinlich ist. Dabei wird die zeitliche Differenz der positiv gewordenen Blutkulturen, die peripher und zentral aus dem Katheter abgenommen wurden, bestimmt. Vorraussetzungen sind dabei die zeitgleiche Abnahme peripherer und zentraler Blutkulturen derselben Blutmenge. Zusätzlich besteht die Möglichkeit einer antibiotischen Lock Therapie. |
Untersuchungsmaterial: Falcon-Röhrchen Blutkulturen (zentral und peripher) |
| Basisdiagnostik: Die gebräuchlichste Methode ist die semiquantitative Anlage nach Maki, wonach die Katheterspitze über eine Blutagarplatte gerollt wird. Die Anzahl der Kolonie bildenden Einheiten (KBE) wird ausgezählt. Bei > 15 Kolonien wird der Erregernachweis als signifikant gewertet. |
| Weiterführende Diagnostik: Da Katheter-assoziierte Infektionen üblicherweise mit einer Bakteriämie einhergehen, sollten neben der Katheterspitze auch immer parallel Blutkulturen abgenommen werden. Der Nachweis eines identischen Erregers sowohl von der Katheterspitze als auch von einer peripher entnommenen Blutkultur gilt als beweisend für eine Katheterassoziierte Infektion oder Bakteriämie im Gegensatz zu einer alleinigen Katheterkolonisation. |
| Sonstiges: Zur Ermittlung der DTTP (differential time to positivity) ist es notwendig, den genauen Entnahmezeitpunkt der Blutkulturen zu vermerken. Vorausgesetzt, die Proben wurden gleichzeitig abgenommen, zeigen Patienten mit Katheterassoziierten Infektionen in zentral vom Katheter abgenommenen Kulturen > 2 Stunden früher als in der peripher entnommenen Kultur ein positives Ergebnis. |
| Inzidenz und Erregerspektrum: Wundinfektionen können als Folge eines Traumas (ambulant) oder nosokomial auftreten. S. aureus ist der häufigste Erreger ambulant erworbener Wundinfektionen. In kontaminierten Wunden finden sich auch Enterobacteriaceae (insbesondere nach penetrierenden Traumata), Clostridium spp. und Bacteroides fragilis und Bacillus spp. Bei ulzerierenden Wunden auf der Grundlage von Durchblutungsstörungen finden sich häufig Mischinfektionen unter Beteiligung gramnegativer Stäbchen und Anaerobiern. Nach Kontamination mit Brackwasser kommt es in seltenen Fällen zu einer Wundinfektion mit Aeromonas hydrophila oder mit Vibrio vulnificus nach Salzwasserexposition. Hierunter werden rapid progressive Verläufe mit begleitender Zellulitis und Myositis beobachtet. Gelegentlich werden auch schwerwiegende chronische Verläufe durch Pilzbefall (Zygomyzeten oder Aspergillus spp.) oder ubiquitäre Mykobakterien insbes. bei Immunsupprimierten beobachtet. Wegen der Besonderheiten im Erregerspektrum sollten dem Mikrobiologen die Art einer Bissverletzung (Menschenbiss, Hundebiss, Katzenbiss o.a.) und Risikofaktoren für bestimmte Infektionen (Immunsuppression, Diabetes mellitus, Hepatopathien, Z.n. Splenektomie, Transplantationen, Steroidtherapie und Auslandsaufenthalte) mitgeteilt werden. In der folgenden Tabelle sind einige charakteristische Erreger bei typischer Wundlokalisation zusammengefasst:
Primär ”saubere” nosokomiale Wundinfektionen sind häufig durch Staphylokokken oder Streptokokken verursacht. Nach gastrointestinalen und genitourethralen Eingriffen finden sich auch Escherichia coli, Proteus mirabilis, Enterokokken und Anaerobier. Bei immunsupprimierten Patienten, insbesondere nach einer Transplantation, kann es neben dem Befall durch Staphylokokken und Enterobacteriaceae zur Besiedelung der Wunde mit selteneren Erregern kommen. Hierzu zählen insbesondere Viren (HSV, VZV, Papillomavirus), Pilze (Candida spp., Dermatophyten) und Mycobacterium chelonae. Eine Wundinspektion kann zusätzliche Hinweise auf verursachende Erreger geben. Ein putrider Geruch findet sich beispielsweise bei Anaerobiern oder Enterokokken, während Pseudomonas spp. oft süßlich riecht. | ||||||||||||||||||
Untersuchungsmaterial - Basisdiagnostik: | ||||||||||||||||||
Untersuchungsmaterial - weiterführende Diagnostik:
Chronische und/oder ulzerierende Wundinfektion: Bei entsprechendem Verdacht sollten außerdem spezifische Untersuchungen beispielsweise auf Mykobakterien, Nokardien, Actinomyces oder Dermatophyten angestrebt werden (Spezifische Untersuchungsanforderung erforderlich).
Verdacht auf Gasbrand (Clostridium spp.) oder zusätzlich zur Basisdiagnostik Gram-Präparat aus Wundabstrich oder Punktat anfordern. |
| Inzidenz und Erregerspektrum: Der Mensch ist das einzige Reservoir von C. diphtheriae. Die Infektion des Menschen erfolgt in der Regel aerogen, bei Hautinfektionen auch durch Schmierinfektion. Bis zu 5 % der Exponierten wird jedoch zu symptomlosen Keimträgern (insbesondere auf der Haut) ohne zu erkranken und damit zu einem Reservoir in nicht-epidemischen Zeiten. Die Diphtherie-Inzidenz ist aufgrund der empfohlenen aktiven Immunisierung in Deutschland selten geworden (< 10 Fälle pro Jahr). Aufgrund einer gewissen Impfmüdigkeit und Absinken des Impfschutzes wird immer wieder der der Gefahr des epidemischen Auftretens der Erkrankung gewarnt. Die Diphtherie wird durch Corynebacterium diphtheriae hervorgerufen. Es sind vier Biotypen bekannt: gravis, intermedius, mitis und belfanti. Eng verwandt mit C. diphtheriae sind C. ulcerans und C. pseudotuberculosis, die auch eine Diphtherie-ähnliche Erkrankung hervorrufen können. C. diphtheriae verursacht eine Infektion des oberen Respirationstraktes und durch Fortleitung des Toxins (ein Phagen-kodiertes A-B-Toxin) auch toxische Symptome an Herz, Nerven und Nieren. Bei der Rachen-Diphtherie ist die Bildung pseudomembranöser Belege, die bei Ablösung zu Blutungen führen und süßlich riechen, typisch, während bei der Nasen-Diphtherie ein blutig-seröser Schnupfen vorherrscht. Toxische Symptome können entweder bereits im Frühstadium der Erkrankung (primär toxischer Verlauf) oder erst nach einigen Wochen (sekundär toxischer Verlauf) in Form einer Myokarditis, Hirnnervenlähmungen, peripheren Neuritis etc. auftreten. Bei der Haut-Diphtherie findet sich klinisch meist eine nekrotisierende Hautläsion. Die Letalität der Erkrankung ist aufgrund der toxischen Wirkungen hoch. Neben der oben beschriebenen typischen Diphtherie-Erkrankung kommen, insbesondere bei Drogen- und Alkohol-Abhängigen, invasive Erkrankungen (Endokarditis, Osteomyelitis, septische Arthritis etc.) durch nicht-toxigene C. diphtheriae-Stämme vor. |
| Untersuchungsmaterial: Rachenabstrich, Nasenabstrich, Tonsillenabstrich, Hautabstrich, sonstige Abstriche befallener Areale (möglichst mehrere Abstriche, vor Gabe von Antibiotika oder Antitoxin!); Rachen- und Tonsillenabstriche am besten unter den Pseudomembranen entnehmen, indem diese mit einer Pinzette hochgehalten werden. Ein Stück der Pseudomembranen sollte ebenfalls in einem sterilen Gefäß zur Diagnostik eingesandt werden. Bei Verdacht auf Hautdiphtherie sollte immer auch ein Nasen- und ein Rachenabstrich abgenommen werden, um den Keimträgerstatus zu erfassen. Die Anzucht des Erregers aus Blutkulturen gelingt nur bei den seltenen invasiven Erkrankungen. Bei der typischen Diphtherie beruhen die systemischen Wirkungen allein auf der Toxinausbreitung und nicht auf einer Keiminvasion. Zweckmäßig ist die gleichzeitige Entnahme einer Serumprobe zur Bestimmung des Impfstatus des Patienten. |
| Basisdiagnostik: Ein Verdacht auf Diphtherie sollte immer auf dem Anforderungsschein dokumentiert werden und es sollte zusätzlich immer der diensthabende Mikrobiologe telefonisch vor Eingang der Probe informiert werden! Da Corynebakterien zur physiologischen Flora der Haut und Schleimhäute gehören, müssen neben Universalnährmedien spezielle Selektiv- und Spezialnährmedien im Labor beimpft werden. Daher ist die gezielte Anforderung auf Corynebacterium diphtheriae unerlässlich! |
| Weiterführende Diagnostik: Aus mikroskopisch auffälligen Primärmaterialien sowie bei Wachstum von verdächtigen Kolonien auf den Nährböden wird in unserem Labor eine PCR-Untersuchung zum Nachweis des Diphtherie-Toxin-Gens durchgeführt. PCR-positive Isolate werden zum Nachweis der Toxin-Produktion mittels Elek-Test an das Kosiliarlaboratorium für Diphtherie gesandt. Für diese weiterführenden Untersuchungen bedarf es keiner gesonderten Anforderung des Einsenders, sondern sie werden im Diphtherie-Verdachtsfall automatisch im Rahmen der Diagnostik durchgeführt. |
Sonstiges: |
| Inzidenz und Erregerspektrum: Zu den Infektionen des Ohres zählen die akute und chronische Otitis media (Mittelohrentzündung) und die Otitis externa (Entzündung des äußeren Ohres und Gehörganges).
1) Akute lokalisierte Otitis externa: Klinisch als Pustel, Furunkel oder Erysipel imponierend, 2) Akute diffuse Otitis externa (= Swimmer's ear): Diffuse Entzündung, Auftreten insbes. in feuchtem, warmen Klima/Umgebung, Erreger: 3) Chronische Otitis externa: Meist bedingt durch Drainage von Sekret aus dem Mittelohr bei beschädigtem Trommelfell, 4) Maligne (invasive) Otitis externa: Nekrotisierende Infektion des Gehörganges, Vorkommen häufig bei Diabetes mellitus.
1. Akute Otitis media
Bei Neugeborenen kommen häufiger S. aureus, Koagulase-negative Staphylokokken und Enterobakterien vor! 2. Chronische Otitis media:
Als seltene Erreger sind ferner Chlamydia pneumoniae, Mycoplasma pneumoniae, Corynebacterium diphtheriae, Mycobacterium tuberculosis, MOTT und Nokardien beschrieben. Weiterhin spielen Schimmelpilze (Aspergillus spp. etc.) eine bedeutende pathogenetische Rolle. Zu erwartenden Kontaminationskeime Die Normalflora des äußeren Ohres und des Gehörganges entspricht der Normalflora der Haut. Es kommen insbes. Staphylococcus epidermidis, Corynebacterium spp., Propionibakterien, vergrünende Streptokokken und Candida (insbes. C. parapsilosis) vor. Auch S. aureus kann zur Normalflora gehören, er wird jedoch in unserem Labor grundsätzlich differenziert und getestet, da er gleichzeitig ein bedeutsamer pathogener Keim ist. Das Mittelohr ist physiologischer Weise steril oder minimal durch Flora des oberen Respirationstraktes (durch Einwanderung durch die Eustachische Röhre) besiedelt | |||||
| Untersuchungsmaterial: Ohrabstriche (umfassen Gehörgangsabstriche und Trommelfellabstriche) Ferner Aspirate, Punktate und Biopsien aus dem Mittelohr | |||||
| Basisdiagnostik: Es sollte stets ein kultureller Erregernachweis angestrebt werden, da dieser in der Regel auch eine Resistenztestung der Bakterien ermöglicht. Die Standard-Untersuchungsanforderung "Erregerkultur und Resistenz" ist als Basisdiagnostik bei V. a. Otitis media und Otitis externa ausreichend und umfasst den Nachweis der oben beschriebenen pathogenen Erreger. Dabei wird routinemäßig auch ein Selektivmedium für den Nachweis von Pilzen (insbes. Aspergillus spp. und Candida spp.) mit angelegt. | |||||
| Weiterführende Diagnostik: Bei anhaltendem Infektionsverdacht aber negativen Kulturergebnissen sollten zunächst weitere Abstriche gewonnen werden und ggf. auch invasiv Untersuchungsmaterial entnommen werden. Bei bestehender Otitis aber fehlendem bakteriellen und fungalen Erregernachweis sollte an eine virale Genese der Otitis gedacht werden und eine entsprechende Diagnostik erfolgen. Zu den viralen Erregern zählen insbesondere Herpes-Simplex-Virus und Varizella-Zoster-Virus. | |||||
| Sonstiges: --- |
| Inzidenz und Erregerspektrum: Die Infektionen des Rachens als entzündliche Reaktionen im Oropharynx umfassen die Pharyngitis und die Tonsillitis, die meist gemeinsam als Tonsillopharyngitis imponieren. Hinzu kommen seltenere Sonderformen, wie die Angina Plaut-Vincent, die durch Anaerobier, insbes. Fusobakterien und Spirochaeten hervorgerufen wird, retropharyngeale Abszesse und die Diphtherie. Die Tonsillopharyngitis gehört zu den häufigsten Gründen für das Aufsuchen eines Arztes für Allgemeinmedizin bzw. eines HNO-Arztes, insbesondere im Kindesalter. Sie zeigt einen Altersgipfel im Alter von 4-7 Jahren, wobei sie meist saisonal gehäuft in der kälteren Jahreszeit auftritt. Tabelle 1 (siehe unten) gibt einen Überblick über die häufigsten Erreger der Tonsillopharyngitis. Die häufigsten bakteriellen Erreger umfassen beta-hämolysierende Streptokokken der Gruppen A, C oder G, des weiteren Arcanobakterium haemolyticum (ein gram-positives Stäbchenbakterium) sowie Mycoplasma pneumoniae. In selteneren Fällen können auch Bordetella spp., Corynebacterium diphtheriae/ulcerans, N. gonorrhoeae, Treponemen, Chlamydien, Yersinien und Anaerobier als Erreger auftreten. | ||||||||||||||||||||||
| Untersuchungsmaterial: Tonsillenabstrich Rachenabstrich | ||||||||||||||||||||||
| Basisdiagnostik: Es sollte stets ein kultureller Erregernachweis angestrebt werden, da dieser in der Regel auch eine Resistenztestung der Bakterien ermöglicht. Die Standard-Untersuchungsanforderung "Erregerkultur und Resistenz" ist als Basisdiagnostik bei V. a. bakterielle Tonsillopharyngitis ausreichend und umfasst den Nachweis von beta-hämolysierende Streptokokken, Arcanobakterium haemolyticum, und Corynebakterien. | ||||||||||||||||||||||
| Weiterführende Diagnostik: Bei V. a. eine Angina Plaut-Vincent (fötiger Geruch, eitrige Tonsillitis) sollte stets ein mikroskopisches Gram-Präparat angefordert werden, da die typischen Erreger (Fusobakterien, Spirochaeten) meist nur mikroskopisch nachgewiesen werden und nicht kulturell anwachsen! Die Verdachtsdiagnose sollte unbedingt auf dem Anforderungsschein angegeben werden, damit eine optimale Diagnostik erfolgen kann und zusätzlich anaerobe Kulturen angelegt werden! Bei negativem Ausfall der Basisdiagnostik sollte auch an die selteneren Erreger einer Tonsillopharyngitis gedacht werden: Mycoplasma pneumoniae und Chlamydia pneumoniae lassen sich kulturell nur schwierig anzüchten. Für die | ||||||||||||||||||||||
| Sonstiges: Tabelle 1 (MiQ 13 2010):
|
Inzidenz und Erregerspektrum: Gelenkprothesen-Infekte unterscheidet man hinsichtlich des Erregerspektrums in Frühinfekte/Spätinfektion - florider Infekt und Spätinfektion - Verdacht auf Infekt. Bei Frühinfekten und floriden Infektionen werden am häufigsten Stapylococcus aureus, Streptokokken und E. coli nachgewiesen. Bei Spätinfektionen (sog. Low-grade Infektionen) werden eher koagulase-negative Staphylokokken, Enterokokken oder auch Propionibakterien nachgewiesen. Die Unterscheidung in Hautkontamination/relevante Erreger ist oft schwierig, die korrekte Materialentnahme und mikrobiologische Diagnostik ist entscheidend (s.u.) |
Untersuchungsmaterial: Biopsien 1-2 cm3 groß im sterilen Vanek-Becher (1 Biopsie pro Becher) Intraoperative Abstriche z. B. bei Prothesenwechsel |
Basisdiagnostik: Gelenkprothesen-Infekt: Es wird empfohlen, bei Gelenkpunktionen 1-3 ml in eine Blutkultur-Ped Flasche und wenn möglich noch 2-3 ml Punktat nativ in der Spritze einzusenden. Erfolgt eine operative Revision sollten 4-6 Gewebeproben ca . 1-2 cm3 groß aus verschiedenen Lokalisationen eingesandt werden. Oberflächliche Fisteln und Ulzerationen sind immer mit Hautflora kontaminiert und für die Diagnostik eines Protheseninfektes nicht geeignet. |
Sonstiges: Bei bakterieller/septischer Arthritis an Blutkulturdiagnostik denken. Bei chronischen Arthritidien, die unter antibakterieller Therapie nicht rückläufig sind, bitte ggf. Rücksprache mit dem Mikrobiologen. |
| Inzidenz und Erregerspektrum: Die Osteomyelitis beschreibt eine Entzündung des Knochens, die nicht nur das Mark des Knochens sondern alle Bauelemente, wie Spongiosa, Kortikalis und Periost betreffen kann. Man unterscheidet zwischen der hämatogenen Osteomyelitis, die durch hämatogene Streuung der Erreger entsteht, und der exogenen Osteomyelitis, bei der die Erreger von außen, z. B. nach Trauma, direkt den Knochen befallen. Die hämatogene Osteomyelitis tritt am häufigsten im präpubertären und späten Erwachsenenalter auf und befällt bevorzugt die Metaphyse langer Röhrenknochen. Die häufigsten Erreger einer hämatogenen Osteomyelitis umfassen Staphylococcus aureus und beta-hämolysierende Streptokokken. Bei Kindern mit fehlendem Impfschutz findet man außerdem Haemophilus influenzae Kapseltyp B und bei Kindern mit Sichelzellanämie enteritische Salmonellen. Bei Erwachsenen kommen als Erreger Enterobakterien, wie E. coli, Serratia marcescens und Pseudomonas aeruginosa hinzu. Zu den seltenen Erregern einer Osteomyelitis gehören Mycobacterium tuberculosis und atypische Mykobakterien (meist Befall der Wirbelkörper), Brucellen (meist Befall der Wirbelkörper und des Sakroiliakalgelenkes) und Aktinomyzeten (meist Befall der Kieferknochen oder Rippen). |
| Untersuchungsmaterial: Blutkulturen Punktate, Biopsien des befallenen Knochens |
| Basisdiagnostik: Ein Verdacht auf Osteomyelitis sollte immer auf dem Anforderungsschein angegeben werden, damit eine optimale Diagnostik erfolgen kann! Blutkulturen sind in über der Hälfte der Fälle positiv und tragen damit wesentlich zur Diagnose bei. Der kulturelle Erregernachweis aus einer Gelenkpunktion oder Nadelaspiration bzw. von Gewebe aus der direkten Umgebung sollte möglichst angestrebt werden, damit nach Resistenztestung der Bakterien eine wirksame spezifische Therapie erfolgen kann. Die Standard-Untersuchungsanforderung "Erregerkultur und Resistenz" ist als Basisdiagnostik bei V. a. Osteomyelitis der langen Röhrenknochen zunächst meist ausreichend. Bei Befall der Wirbelkörper oder anderer Knochen (siehe oben) sollten aufgrund der Epidemiologie der spezifischen Erreger jedoch stets Spezialuntersuchungen angefordert werden (siehe unter "Weiterführende Diagnostik"). |
| Weiterführende Diagnostik: Bei fehlendem Erregernachweis in den Standard-Kulturverfahren sowie bei Befall der Wirbelkörper oder anderer Knochen untypischer Lokalisationen sollte der Nachweis folgender Erreger spezifisch angefordert werden:
|
| Sonstiges: Bei chronischer Osteomyelitis, die bereits längere Zeit antibiotisch behandelt wurde, können als Erreger sogenannte Small-colony-Variants von Staphylokokken (insbes. S. aureus) vorkommen. Hierbei handelt es sich um Varianten des Erregers, bei denen die sonst typischen Spezieseigenschaften (Koagulasereaktion, Pigmentierung, Hämolyseeigenschaften) nicht oder nur geringgradig ausgeprägt sind und die aufgrund spezifischer Elektronentransportdefekte eine erhöhte intrazelluläre Erregerpersistenz und damit verminderte Ansprechrate auf die gezielte antimikrobielle Therapie aufweisen. Ein Nachweis dieser Small-colony-Variants wird im Labor angestrebt, sofern die Verdachtsdiagnose "Osteomyelitis" auf der Anforderung erkenntlich ist! |
| Inzidenz und Erregerspektrum: Die Mukoviszidose (Cystische Fibrose) ist eine autosomal rezessiv vererbte Erkrankung, die zu einer generalisierten Störung des sekretorischen Epithels aller exokrinen Drüsen führt. Sie wird meist durch Mutationen im Cystic-Fibrosis-Transmembrane-Conductance-Regulator(CFTR)-Gen, das für Salz- und Wassertransportvorgänge in Zellen notwendig ist, ausgelöst. Dies führt zu schweren Veränderungen insbesondere an Pankreas, Darm und Respirationstrakt. Im Respirationstrakt wird ein sehr zäher Schleim produziert, der die Selbstreinigungsfunktion der Alveolen beeinträchtigt. Es siedeln sich Bakterien an, die zu chronischen Entzündungen und zu einem Umbau des Lungengewebes führen. Die Lungeninsuffizienz ist hauptverantwortlich für die verminderte mittlere Lebenserwartung. Das Erregerspektrum bei Atemwegsinfektionen entwickelt sich mit dem Alter recht charakteristisch: Im Säuglings- und Kleinkindalter dominieren Staphylococcus aureus und Haemophilus influenzae. Ab dem Schulkindalter folgt die chronische Besiedlung mit Pseudomonas aeruginosa, häufig in einer mukoiden Variante. 1-5 % der älteren Patienten sind mit Burkholderia cepacia besiedelt, was mit einer ungünstigen Prognose einhergeht. Es gibt weitere typische Erreger des Respirationstraktes von Mukoviszidose-Patienten, wobei deren pathogenetische Bedeutung noch unklar ist (Pseudomonas spp., Stenotrophomonas maltophilia, Achromobacter xylosoxidans, Ralstonia pickettii, atypischen Mykobakterien (MOTT)). Außerdem lassen sich bei Mukoviszidose-Patienten häufig Aspergillus fumigatus und Candida spp. nachweisen, wobei ca. 5 % der Patienten eine allergische bronchopulmonale Aspergillose zeigen. |
| Untersuchungsmaterial: Sputum, Bronchialsekret, BAL (mind. 500 µl) Rachenabstrich |
| Basisdiagnostik: Der Erregernachweis erfolgt durch kulturelle Anzucht auf Universal- und Selektivmedien und anschließender Differenzierung und Resistenztestung. Dabei werden grundsätzlich auch Selektivnährmedien zum Nachweis von Pseudomonaden, Pilzen und Burkholderien eingesetzt. |
| Sonstiges: Das besondere Erregerspektrum, das durch sonst eher seltene Keime und durch z. T. langsam wachsende und schwierig zu differenzierende Erreger gekennzeichnet ist, verlangt spezielle Anlage- und Differenzierungsmethoden sowie persönliche Erfahrung. In unserem Labor ist daher ein spezieller "Mukoviszidose-Arbeitsplatz" eingerichtet. |
Inzidenz und Erregerspektrum: Bei ambulanter Pneumonie wurde für Deutschland aufgrund der CAPNETZ-Daten die herausragende Bedeutung von Streptococcus pneumoniae bestätigt. Deutlich seltener sind Infektionen durch Mycoplasma pneumoniae, Haemophilus influenzae, Enterobakterien, Legionellen, S. aureus oder respiratorischer Viren. Gelegentlich können jedoch Erreger wie Staphylococcus aureus, Streptococcus pyogenes, Streptococcus pneumoniae, Neisseria meningitidis, Haemophilus influenzae auch in der physiologischen Atemwegsflora von Gesunden nachgewiesen werden. | ||||||||||||||||||||||||||||||||||||||||||||||||||||
Untersuchungsmaterial:
| ||||||||||||||||||||||||||||||||||||||||||||||||||||
| Weiterführende Diagnostik: Tabelle 2 (siehe unten) gibt einen Überblick über die Diagnostik verschiedener Pneumonien. Bei Risikopatienten und Verdacht auf seltene Erreger sollte frühzeitig invasive Diagnostik betrieben werden (BAL) Die serologische und molekularbiologische Diagnostik (M. pneumoniae, Legionella spp., C. pneumoniae, C. psittaci, Coxiella burnetii u.a.) und der Antigennachweis im Urin(L. pneumophila; S.pneumoniae) bleibt speziellen Verdachtsdiagnosen vorbehalten. Bei V. a. pulmonale Tuberkulose können neben oben genannter Mikroskopie und Kultur die Mykobakterien des Mycobacterium tuberculosis-Komplex mittels Polymerase-Ketten-Reaktion (PCR) aus respiratorischen Sekreten oder Pleurapunktat nachgewiesen werden. Die PCR ist jedoch aufgrund ihrer Empfindlichkeit und möglicher falsch positiver Ergebnisse nur bei positivem Direktpräparat oder sehr dringendem Verdacht auf eine pulmonale Tbc sinnvoll. Der Nachweis von Pneumocystis jiroveci aus bronchoskopisch gewonnenen Materialien ist aussagekräftiger als aus Sputum. Der Erreger wird mikroskopisch mittels Fluoreszenzmikroskopie nachgewiesen. Bei negativer Mikroskopie und hochgradig klinischem Verdacht kann ein DNA-Nachweis aus der BAL versucht werden (nur nach telefonischer Rücksprache). Pleurapunktat: Verschiedene Erreger können eine parapneumonische Pleuritis mit Pleuraerguss hervorrufen. Die häufigsten mikrobiellen Erreger sind S. pneumoniae, Legionella spp., M. pneumoniae, H. influenzae, Klebsiella spp., Pneumocystis jiroveci. Es wird der Erregernachweis durch aerobe und anaerobe Kultivierung angestrebt. | ||||||||||||||||||||||||||||||||||||||||||||||||||||
Tabelle 1: Häufige Erreger tiefer Atemwegsinfektionen in verschiedenen Altersgruppen
Tabelle 2: Diagnostik verschiedener Pneumonien
Mit Risikofaktor für multiresistente Erreger:
|
| Inzidenz und Erregerspektrum: Die Tuberkulose (Tbc) des Menschen wird in Deutschland am häufigsten durch Mycobacterium tuberculosis verursacht. Selten kommen M. bovis (Reservoir in Rindern) und M. africanum (in Afrika) als Erreger vor. Bei Immunsupprimierten kann der Tuberkulose-Impfstamm M. bovis BCG eine Impf-Tuberkulose („BCGitis“) hervorrufen. Eine Infektion durch M. microti, einem Pathogen für Nager, stellt eine Rarität bei Immmunsupprimierten dar. Aufgrund ihrer engen genotypischen und phänotypischen Verwandtschaft werden M. tuberculosis, M. bovis, M. bovis BCG, M. africanum und M. microti zum Mycobacterium tuberculosis-Komplex zusammengefasst. |
Untersuchungsmaterial:
|
Basisdiagnostik: (Kontrollbedürftig): 1 – 9 säurefeste Stäbchen je 100 Gesichtsfelder, |
Weiterführende Diagnostik: Der QuantiFERON®-Test ist ein indirekter Test zum Nachweis einer M. tuberculosis-Infektion. Dieser ist eine Alternative zum Tuberkulin-Hauttest nach Mendel-Mantoux. Im Gegensatz dazu zeigt der QuantiFERON®-Test keine Kreuzreaktion mit dem Tuberkulose-Impfstamm (BCG). Die Ergebnisse des QuantiFERON®-Tests müssen in Kombination mit der epidemiologischen Historie des einzelnen Patienten, seinem derzeitigen Gesundheitszustand und sonstiger diagnostischer Untersuchungen betrachtet werden. Ein positives Testergebnis kann nicht zwischen einer akut behandlungsbedürftigen und einer latenten Tuberkulose unterscheiden. Eine weiterführende Diagnostik zum Ausschluss einer aktiven Tuberkulose (siehe oben) muss ggf. durchgeführt werden. |
| Sonstiges: Für nachgewiesene M. tuberculosis-Komplex Isolate eine Resistenztestung durchgeführt. Diese dauert in der Regel ca. 2 Wochen. |
| Inzidenz und Erregerspektrum: Harnwegsinfektionen stellen die häufigste nosokomiale Infektion dar. Sie werden unterschieden in
| |||||
Untersuchungsmaterial: Bei Katheterurin kann bereits im Katheterbeutel eine Keimvermehrung stattfinden. Er sollte daher stets aus der dafür vorgesehenen Punktionsstelle am Katheter gewonnen werden. | |||||
| Basisdiagnostik: Nativurin in ein Borsäureröhrchen überführen. Sofern Nativurin im Vanek-Becher eingeschickt wird, ist ein schneller Probentransport notwendig, um das Wachstum von Kontaminanten im Urin zu verhindern. Er darf bis zum Eintreffen im Labor max. 30 Min. bei Raumtemperatur aufbewahrt werden, ansonsten ist eine Kühlung bei 2-8 °C erforderlich. | |||||
| Weiterführende Diagnostik: Bei Diskrepanz der klinischen und bakteriologischen Befunde ist die erneute Einsendung einer Urinprobe sinnvoll. Infektionserreger, die im Rahmen der Basisdiagnostik nicht erfasst werden und für die Spezialanforderungen erforderlich sind, umfassen
| |||||
Befundinterpretation: | |||||
| Weitere diagnostische Maßnahmen: Für die Beurteilung eines bakteriologischen Urinbefundes kann auch die Kenntnis einer Leukozyturie nützlich sein. Bei einer Harnwegsinfektion besteht in der Regel eine Leukozyturie. Fehlt die Leukozyturie bei signifikanter Bakteriurie, weist dies auf Entnahmefehler hin. Bei Leukozyturie ohne signifikante Bakteriurie ist an eine Urethritis oder an untypische Erreger, wie z.B. Mycobacterium tuberculosis, zu denken.
|
| Inzidenz und Erregerspektrum: Die Lues oder Syphilis wird durch den Spirochaeten Treponema pallidum ssp. hervorgerufen. Die Syphilis wird nahezu ausschließlich durch sexuelle Kontakte übertragen. Der Kliniker teilt die Syphilis in verschiedene Stadien ein. Primärstadium:T. pallidum durchdringt die Haut und Schleimhäute in der Regel durch Mikroverletzungen. Die Inkubationszeit ist abhängig von der Inokulumdichte der übertragenen Erreger. An der Infektionsstelle bildet sich meist nach 5-90 Tagen eine Läsion. Typisch ist eine einzelne, schmerzlose, indurierte Ulzeration mit sauberem Untergrund (Ulcus durum, harter Schanker, Primäraffekt). Etwa eine Woche nach Auftreten des Ulcus durum vergrößern sich die regionalen Lymphknoten. Der Komplex aus Ulcus durum und Lymphknotenschwellung heißt Primärkomplex. Das Ulcus durum heilt 3-6 Wochen nach Auftreten unter Narbenbildung ab, während die Schwellung des lokalen Lymphknotens monatelang bestehen bleiben kann. Sekundärstadium: Die sekundäre Syphilis entwickelt sich aufgrund einer hämatogenen Ausbreitung der Erreger und tritt 3-6 Wochen nach dem Primäraffekt auf. Dieses Stadium ist charakterisiert durch variable Erscheinungen an Haut und Schleimhäuten. Charakteristisch sind makulo-papulöse Exantheme (auch palmar und plantar!), Plaques muqueuses der Zunge und Condylomata lata genital und perianal. Die Lymphknoten sind generalisiert geschwollen, es kann ein leichtes Fieber bestehen, ebenso Entzündungen im Halsraum und Arthralgien. Miterkrankungen innerer Organe sind möglich. Das Sekundärstadium der Syphilis dauert Wochen bis Monate. Wenn die Krankheit unbehandelt bleibt, kann es zum Rezidiv kommen. Latenz: Als Latenz werden diejenigen Perioden nach Abheilen des Primäraffekts bezeichnet, in denen keine klinischen Symptome vorliegen. Der Erreger ist auch während der Latenz im Körper vorhanden. Die Latenz kann weniger als ein Jahr andauern oder auch lebenslang bestehen. Sie unterteilt sich in die Frühlatenz, d. h. die erscheinungsfreie Zeit in den ersten vier Jahren nach Krankheitsbeginn, und die Spätlatenz, d.h. die erscheinungsfreie Zeit danach. Tertiärstadium: Bis zu 35 % aller unbehandelten Syphilisfälle treten in das Tertiärstadium ein. Nach einer Latenzzeit von 1-20 Jahren und länger können die unterschiedlichen Manifestationsformen der tertiären Syphilis auftreten. Die Symptomatik ist außerordentlich vielfältig. An der Haut und den Schleimhäuten können tuberöse Veränderungen (Lues tuberosa) und die heute sehr seltene Lues gummatosa auftreten. Die Gumma-Bildung kann alle Schichten zwischen Haut und Knochen, aber auch das Herz, das Gehirn oder parenchymatöse Organe betreffen. Weitere Organmanifestationen der tertiären Syphilis sind die Opticus-Atrophie, die Innenohrschwerhörigkeit (meist bei konnataler Syphilis) und das syphilitische Aneurysma der Aorta. Im ZNS ist eine Vielfalt von neurologischen Symptomenkomplexen möglich. Die klassischen Formen der Neurosyphilis, progressive Paralyse und Tabes dorsalis, die auch als quartäre Syphilis bezeichnet werden, sind heute relativ selten. Syphilis und Schwangerschaft: Eine unbehandelte Syphilis kann den Schwangerschaftsverlauf entscheidend beeinflussen. Spontanabort, Totgeburt, Frühgeburt oder perinataler Tod sind möglich. Frühgeburt und niedriges Geburtsgewicht finden sich bei 10-40 % der Kinder unbehandelter Mütter. Die vertikale Transmissionsrate unbehandelter Schwangerer beträgt bei Primärsyphilis 70-100 %, in der Frühlatenz 40 % und in der Spätlatenz 10 %. Grundsätzlich gilt, dass je länger das Zeitintervall zwischen Infektion und Schwangerschaft ist, desto geringer ist das Risiko für das Kind. Die Infektion des Fetus kann bereits im I. Trimenon erfolgen. Die Erkrankung des Kindes resultiert jedoch wahrscheinlich nicht direkt aus dem Treponemenbefall, sondern ist Folge von Entzündungsreaktionen, die erst nach hinreichender Reifung des Immunsystems auftreten können. Eine Gefährdung des Fetus durch die Syphilis ist somit erst ab dem 4.-5. Schwangerschaftsmonat zu erwarten. Syphilis connata: Das infizierte Neugeborene kann asymptomatisch sein oder es zeigt sehr unterschiedliche Symptome von diskreten Erscheinungen hin bis zu einem Multiorganbefall. Die postnatalen klinischen Symptome werden in ein Frühstadium (Auftreten der Symptome innerhalb der ersten 2 Lebensjahre) und ein Spätstadium (Auftreten der Symptome nach dem zweiten Lebensjahr) gegliedert. Symptome der Frühphase sind eine persistierende Rhinitis, Hepato- und Splenomegalie, Glomerulonephritis, generalisierte Lymphadenopathie, Hautveränderungen und auffällige Befunde im Liquor. Knochenläsionen treten meist innerhalb von 8 Monaten nach der Geburt bei früher kongenitaler Syphilis auf. Typisches Merkmal des Spätstadiums ist die Hutchinson-Trias, bestehend aus Tonnen-Zähnen, Keratitis parenchymatosa und Innenohrschwerhörigkeit. Weiter können sich zahlreiche Veränderungen am Skelett finden als Folge chronischer Entzündungsprozesse. Auch eine meist asymptomatische Neurosyphilis ist bei bis zu einem Drittel der Patienten, die älter als 2 Jahre sind, nachweisbar. Zur Vermeidung von Schwangerschaftskomplikationen und der Lues connata ist die Durchführung eines T. pallidum-Antikörpersuchtests bei allen Schwangeren innerhalb des 1. Trimenon in den Mutterschaftsrichtlinien vorgeschrieben. |
Untersuchungsmaterial:
|
| Basisdiagnostik: Die Syphilisdiagnostik beruht auf einer serologischen Stufendiagnostik (siehe hierzu auch Ausführungen unter "Sonstiges"). Als Screeningtest kommt der ELISA zum Einsatz. |
| Weiterführende Diagnostik: Weiterführende serologische Teste werden vom Labor entsprechend der Befundkonstellation und der klinischen Angaben eigenständig durchgeführt. |
| Sonstiges: Hinweise zu den serologischen Untersuchungsverfahren: Im Rahmen der Erstdiagnostik einer Lues werden bei positivem ELISA der FTA-Abs-Test, IgM-recomeLine-Blot und VDRL-Test durchgeführt. Bei Folgeuntersuchungen werden routinemäßig nur der ELISA und der VDRL-Test (beide quantitativ) durchgeführt.
|
| Besonderheiten zur Diagnostik der Neurosyphilis: Die Neurosyphilis ist Folge einer systemischen Infektion mit T. pallidum. Da der Erreger auf dem Blutwege die Organe erreicht und es sich somit niemals um eine isolierte Infektion des ZNS handelt, genügt auch bei klinischem Verdacht auf eine Neurosyphilis zunächst die Serumuntersuchung. Bei positiver Basisdiagnostik ist dann die parallele Untersuchung von am gleichen Tag entnommenen Proben von Serum und Liquor erforderlich.(externe Untersuchung)
|
| Inzidenz und Erregerspektrum: Leitkeim bei der akuten und chronischen Prostatitis ist Escherichia coli, gefolgt von anderen Spezies aus der Familie der Enterobakterien. Die Rolle von Chlamydia trachomatis und Ureaplasma spp. bei der chronischen bakteriellen Prostatitis ist umstritten. Zu den ungewöhnlichen oder besonders anspruchsvollen Erreger einer Prostatitis gehören:
|
| Untersuchungsmaterial: Der Infektionserregernachweis bei der Prostatitis erfolgt aus Prostatasekret und/oder einer Urinprobe. Bei der routinemäßigen Untersuchung werden schnell wachsende, anspruchslose Infektionserreger erfasst. Nur im Einzelfall muss das Nachweisspektrum auf gezielte Untersuchungen und Untersuchungsanforderungen (siehe oben) erweitert werden. Zur besseren Lokalisation der Infektion ist zu empfehlen, die Erregerkeimzahl in verschiedenen Urinproben zu bestimmen. Bewährt hat sich die sog. 4- bzw. 2-Gläserprobe (nur 2. und 4.):
|
| Basisdiagnostik: Erreger und Resistenz. Erfasst die schnell wachsenden, anspruchslosen Infektionserreger. |
| Weiterführende Diagnostik: Zum Nachweis von Haemophilus influenzae und/oder obligaten Anaerobiern ist eine gezielte Anforderung erforderlich. Zum kulturellen Nachweis von Neisseria gonorrhoeae gezielte Anforderung und unverzüglicher Transport ins Labor, zum Nukleinsäurenachweis Urinprobe einsenden. Bei Verdacht auf C. trachomatis Urinprobe (Erststrahlurin in TPM) für Nukleinsäurenachweis einsenden. Mycobacterium tuberculosis: gezielte Anforderung auf Kultur und Mikroskopie; Bedeutung der Nukleinsäureamplifikation zur Detektion von M. tuberculosis aus dem Prostatasekret unklar. Ureaplasma spp. wird kulturell aus dem Prostatasekret nachgewiesen, Verwendung spezieller Transportmedien und spezifische Anforderung erforderlich. |
| Bewertung: Eine um einen Faktor von mindestens 10 höhere Keimzahl in der Urinprobe nach der Prostata-Massage spricht dafür, dass der Infektionserreger in der Prostata lokalisiert ist. |
| Inzidenz und Erregerspektrum: Das Erregerspektrum erfasst:
Chlamydia trachomatis ist mit ca. 50 % der häufigste Urethritiserreger, gefolgt vermutlich von Mycoplasmen und Trichomonaden. |
| Untersuchungsmaterial: Zum Nachweis von Chlamydia trachomatis, Neisseria gonorrhoeae und/oder Trichomonas vaginalis mittels Nukleinsäureamplifikation ist die erste Portion einer Harnprobe oder ein Urethralabstrich zu verwenden. Sensitivität und Spezifität dieser Untersuchung liegen bei über 95 %. Der Nachweis von Ureaplasmen / Mycoplasmen erfolgt kulturell aus dem Urethralabstrich. Zusätzlich kann ein molekularbiologischer Nachweis (PCR) von Ureaplasma spp. erfolgen. Der kulturelle Nachweis von Gonokokken erfolgt aus einem Urethralabstrich, unverzüglicher Transport der Probe ins Labor. |
Basisdiagnostik: |
| Sonstiges: Der kulturelle Chlamydiennachweis ist sehr aufwendig und daher routinemäßig nicht verfügbar. Es gibt kein zuverlässiges serologisches Verfahren zum Nachweis uropathogener Mycoplasmen. Der Antikörpernachweis zur Diagnose einer Urethritis durch Chlamydien und Gonokokken ist unzuverlässig. |
| Inzidenz und Erregerspektrum: Bei der Bakteriellen Vaginose ist die normale Standortflora der Vagina, insbesondere die Gruppe der Laktobazillen ("Döderlei-Bakterien"), unterdrückt. Aufgrund der daraus resultierenden Alkalisierung des pH-Wertes wird das Wachstum von Gardnerella vaginalis und anaeroben Bakterien gefördert. Häufig kommt es damit zum Auftreten von Krankheitsbeschwerden. Die Diagnose der Bakteriellen Vaginose erfolgt in der Praxis anhand folgender vier Kriterien (Methode nach Amsel), von denen mindestens drei positiv sein müssen:
Ein alleiniger Nachweis von Gardnerella vaginalis im Vaginalabstrich ist nicht hinweisend auf eine Bakterielle Vaginose, da Gardnerella auch bei gesunden Frauen in der Vaginalflora anzutreffen ist! |
| Untersuchungsmaterial: Vaginalabstrich |
| Basisdiagnostik: Beurteilung eines nach Gram gefärbten Präparates mit semiquantitativer Erfassung von Laktobazillen, Gardnerellen und obligaten Anaerobiern. Somit kann eine Aussage über das Gleichgewicht der Erreger im Vaginalsekret getroffen werden. |
| Weiterführende Diagnostik: Ein kultureller Erregernachweis mit anschließender Resistenztestung ist für Fragestellung "Bakterielle Vaginose" nicht sinnvoll. |
| Sonstiges: Die Probe sollte sofort nach Entnahme vom untersuchenden Arzt auf einen sterilen Objektträger aufgebracht und luftgetrocknet werden. Für den Versand wird der betupfte Objektträger nach Trocknung der Probe in einem dafür vorgesehenen, bruchsicheren Plastikbehälter verschickt. Die Plastikbehälter werden dem Einsender von der Abteilung Medizinische Mikrobiologie und Hygiene zur Verfügung gestellt (bitte anfordern unter Tel. 65380). |
Tage bis Wochen nach Infektion bildet sich an der Eintrittsstelle ein Erythema migrans aus. Die Hauterscheinung kann über Wochen persistieren (Erythema chronicum migrans). Eine weitere Manifestation stellt neben multiplen Erythemen die Lymphadenitis benigna cutis (Borrelien-Lymphozytom) dar. Disseminierte Frühmanifestation: Spätmanifestation: |
| Untersuchungsmaterial: Serum (mind. 500 µl) Liquor (mind. 1 ml) |
| Basisdiagnostik: Die mikrobiologische Diagnostik der Borreliose erfolgt durch die Serologie (Antikörpernachweis). Dazu wird eine Stufendiagnostik durchgeführt, die im ersten Schritt einen Suchtest (ELISA) und in einem zweiten Schritt einen Bestätigungstest (Immunoblot) vorsieht. |
| Weiterführende Diagnostik: Zur Diagnose einer Neuroborreliose ist der Nachweis intrathekal synthetisierter Antikörper erforderlich. Daher erfolgt die Bestimmung des Liquor/Serum-Index durch Messung der spezifischen Antikörper in Blut und Liquor. Die Gesamt-IgG-Konzentration von Serum und Liquor sowie die Konzentration des Serumalbumins und Liquoralbumins werden in der Abteilung Klinische Chemie bestimmt, was vom Einsender veranlasst werden muss (ggf. telefonische Rücksprache + Info)! |
| Sonstiges: Klinische Kriterien (Anamnese, Symptomatik, Befund) sind entscheidend für die Diagnosestellung und für die diagnostische Bewertung der mikrobiologischen Laborbefunde. Verlaufsuntersuchungen sind dann sinnvoll, wenn die Erstuntersuchung ein grenzwertiges Ergebnis erbrachte oder die Erstuntersuchung negativ befundet wurde und der klinische Verdacht einer frühen Borreliose besteht. |
| Inzidenz und Erregerspektrum: Die Inzidenz der bakteriellen Meningitis liegt in Deutschland bei ca. 1 Erkrankung pro 100 000 Einwohner. Als häufigste Erreger kommen
vor. Die Inzidenz der invasiven Meningokokken-Erkrankungen liegt bei 0,55/100.00 Einwohner. H. influenzae ist nach Aufnahme der aktiven Impfung in den Impfplan für Kinder als Meningitis-Erreger selten geworden. |
| Untersuchungsmaterial: Primär sollte der Nachweis des Erregers aus dem Liquor angestrebt werden. Dieser sollte vor einer Antibiotika-Gabe gewonnen werden, da eine Antibiotika-Therapie die Anzahl der Bakterien im Liquor um das 102- bis 106-fache reduziert. Für den mikroskopischen bzw. kulturellen Nachweis der oben genannten Erreger sind 1-2ml Liquor i.d.R. ausreichend, die Nachweiswahrscheinlichkeit der Erreger steigt jedoch mit zunehmender Liquormenge. Falls eine tuberkulöse Meningitis ausgeschlossen werden soll, sind zusätzlich mindestens 3-5 ml Liquor erforderlich. Die Erregerkonzentration im Liquor kann bei einer Meningits unter Umständen nur 10 CFU/ml betragen. Der Liquor sollte möglichst schnell zur Verarbeitung in das mikrobiologische Labor gelangen. Ist dies aufgrund einer Abnahme außerhalb der Dienstzeiten nicht möglich, so sollte er bei Raumtemperatur bis zum Transport gelagert werden und zusätzlich eine Blutkulturflasche Kinder mit 1-5 ml Liquor beimpft werden. Nach Beimpfung sollte sie bis zum Transport ins Labor bei Raumtemperatur gelagert werden. Zusätzlich zur Liquordiagnostik ist die Einsendung von Blutkulturen empfehlenswert, da die meningeale Invasion der Bakterien in der Regel aus dem Blut erfolgt. Blutkulturen stellen bei Hirndruckzeichen die einzige Möglichkeit dar, die Erreger zu identifizieren und anzuzüchten. |
| Basisdiagnostik: Im Rahmen der Basisdiagnostik genügt die Anforderung „Erreger und Resistenz“. Einige Tropfen des Liquors werden mittels Cytozentrifugation angereichert und nach Gram und mit Methylenblau gefärbt. Die Anzahl und Art der Zellen (Neutrophile Granulocyten, mononukleäre Zellen, Erythrocyten) und Bakterien werden semiquantitativ bestimmt. Die Gram-Färbung erlaubt eine Identifikation der Bakterien in 60-90 % der Meningitiden. Die Sensitivität hängt jedoch direkt von der Konzentration der Bakterien im Liquor ab: Sie liegt bei Konzentrationen von
Die Zahl der Neutrophilen kann sich bereits bei einer Lagerung von 2 Stunden um 50 % reduzieren. Es sollte daher möglichst bald nach Liquorabnahme eine Zellzählung erfolgen. Der Rest des Liquors wird für die Beimpfung von speziellen Nährböden und Flüssigmedien zur Anzucht und Identifizierung der Erreger genutzt. Eine Resistenztestung erfolgt bei allen aus dem Liquor isolierten Bakterien und liegt in der Regel spätestens nach 48 Stunden vor. |
Weiterführende Diagnostik: Für spezielle Verdachtsfälle bei ambulant erworbenen Meningitisfällen steht eine Multiplex-PCR auf die häufigsten Meningitis-Erreger zur Verfügung. Diese wird nur in Ergänzung der konventionellen Meningitis-Diagnostik (Mikroskopie+Kultur) und nach vorheriger Absprache mit dem Mikrobiologen durchgeführt. |
Sonstiges: Bei negativem Erregernachweis und anhaltendem Meningokokken-Verdacht wird der Liquor zur PCR in das Meningokokken-Referenzlabor geschickt. |
| Inzidenz und Erregerspektrum: Der Parasit Toxoplasma gondii verursacht die Toxoplasmose, eine meist gutartige aber bei immunsupprimierten Patienten sowie bei pränataler Infektion auch sehr schwerwiegend verlaufende Infektionskrankheit. Toxoplasma gondii, ein einzelliger, obligat intrazellulärer Parasit, kommt weltweit vor und verursacht die Toxoplasmose des Menschen. Katzen sind in Europa die häufigsten Endwirte. Sie scheiden einige Tage nach Infektion Millionen infektiöse Oozysten von T. gondii aus. Die Oozysten sind sehr umweltresistent und können sich über lange Zeit im Erdboden halten. Sie können dann auch von Nutztieren, z. B. Schweinen, aufgenommen werden und in diesen persistieren. Die Infektion des Menschen erfolgt in der Regel durch perorale Aufnahme von Oozysten (Kontakt mit Katzenausscheidungen, kontaminierte Nahrungsmitteln, Verzehr unzureichend erhitzten zystenhaltigen Fleisches etc.). Die Infektion verläuft beim Menschen in der Regel asymptomatisch, nur bei 5 % der akut infizierten immunkompetenten Patienten kommt es nach einer Inkubationszeit von 2-3 Wochen zu Fieber, Lymphknotenschwellungen, Kopfschmerzen als Zeichen einer Enzephalitis oder auch zu einer Chorioretinitis. Der Erreger persisitiert nach Primärinfektion meist lebenslang in Lymphknoten und im ZNS, ohne klinische Symptome hervorzurufen. Im jungen Erwachsenenalter liegt die Durchseuchung in Deutschland bei 25-55 %. Bei immunsupprimierten Patienten kann es zu einer Reaktivierung des Erregers, klinisch in der Regel verbunden mit einer Enzephalitis, kommen. Bei Immunkompetenten kann eine Reaktivierung mit einer Chorioretinitis einhergehen. Die Toxoplasmose hat eine besondere Bedeutung in der Schwangerschaft, da es hier, auch bei asymptomatischem Verlauf der Mutter, zur schwerwiegenden Schädigung des Fetus kommen kann. Nur die Erstinfektion während der Schwangerschaft führt zur pränatalen Toxoplasmose-Infektion des Kindes. Je nach Infektionszeitpunkt während der Schwangerschaft unterscheidet sich das Infektionsrisiko des Kindes: So führt eine Infektion der Mutter im ersten Trimenon der Schwangerschaft zwar selten (4-15 %) zur diaplazentaren Transmission des Parasiten, eine Infektion des Embryos ist dann aber nicht selten mit Abort oder schwersten klinischen Symptomen des Neugeborenen verbunden. Im Gegensatz dazu findet bei Infektion der Mutter während des letzten Trimenons zwar häufig (60 %) eine Übertragung des Parasiten auf das Kind statt, die klinische Symptomatik beim Neugeborenen ist dann jedoch geringer ausgeprägt und kann sogar gänzlich fehlen. Im Gegensatz zu anderen europäischen Ländern ist derzeit eine routinemäßig durchgeführte Untersuchung auf Toxoplasmose während der Schwangerschaft nicht vorgesehen, weil die auf den Nachweis von IgM- und IgG-Antikörpern beschränkten Testsysteme in manchen Fällen keine eindeutigen Aussagen zum Infektionsstatus erlauben. | ||||||||
| Untersuchungsmaterial: Serum für den Antikörper-Nachweis Liquor [DNA-Nachweis mittels PCR(externe Untersuchung)] in Sonderfällen EDTA-Blut, Fruchtwasser, Augenkammerflüssigkeit [DNA-Nachweis (externe Untersuchung)] Lymphknoten-Biopsien, Hirnbiopsien [Mikroskopie und DNA-Nachweis (externe Untersuchung)] | ||||||||
| Basisdiagnostik: Die Diagnosestellung einer Toxoplasmose erfolgt serologisch im Rahmen einer Stufendiagnostik, wobei nur die vom Paul-Ehrlich-Institut zugelassenen Diagnostika angewendet werden dürfen. Der Suchtest besteht bei uns aus dem VIDAS TOXO IgG- und IgM-Test. Bei negativem Ausfall des IgM-Nachweises und negativem Nachweis von IgG-Antikörpern werden keine weiteren Untersuchungen durchgeführt. Vorgehen bei positivem Suchtest:
Bei Eingang von Verlaufsseren werden IgM-Antikörper und IgG-Antikörper im Parallelansatz verglichen. Bei besonderen Befundkonstellationen, z. B. bei positiven IgM- und IgG-Antikörpern bei Schwangeren, werden in der 3. Stufe weiterführende Teste durchgeführt (siehe auch unter "Weiterführende Diagnostik"):
| ||||||||
Weiterführende Diagnostik:
Diagnostik bei Verdacht auf Lymphknoten-Toxoplasmose
| ||||||||
| Sonstiges: Bei zurückliegender Infektion mit T. gondii kann es unter der Immunsuppression zu einer Reaktivierung des Erregers kommen, die am häufigsten in Form einer zerebralen Toxoplasmose auftritt. In der Regel werden spezifische IgG-Antikörper mittels ELFA nachgewiesen. Eine Reaktivierung geht in der Regel nicht mit einem Anstieg der IgG-Antikörper einher. Beim Nachweis Toxoplasma-spezifische IgM-Antikörper ist immer eine mögliche IgM-Persistenz abzuklären. Die Untersuchung von Liquor mittels PCR ist umstritten und fällt bei zerebraler Toxoplasmose unterschiedlich aus. |
Leistungsverzeichnis nach Erregern
Klinik: |
Untersuchungsmaterial: |
Untersuchungsmethode(n): |
Besonderheiten: |
Dauer der Untersuchung: |
Klinik: |
Untersuchungsmaterial: |
Untersuchungsmethode(n): |
Besonderheiten: Aufgrund des großen Aufwands und der Seltenheit der Erkrankung strenge Indikationsstellung und Rücksprache mit einem Laborarzt. |
Dauer der Untersuchung: |
Klinik: |
Untersuchungsmaterial: |
Untersuchungsmethode(n): |
Besonderheiten: Zum Screening auf multiresistenten Acinetobacter baumannii complex (Risikogruppe siehe Hygieneplan) separate Anforderung auf „MRGN-Screening“ erforderlich. |
Dauer der Untersuchung: |
Klinik: |
Untersuchungsmaterial: |
Untersuchungsmethode(n): |
Besonderheiten: |
Dauer der Untersuchung: |
Klinik: Wundinfektionen, Sepsis, Augeninfektionen und Meningitis, gastrointestinale Infektionen: vor allem bei Immunsupprimierten |
Untersuchungsmaterial: |
Untersuchungsmethode(n): |
Besonderheiten: |
Dauer der Untersuchung: |
Klinik: |
Untersuchungsmaterial: |
Untersuchungsmethode(n): |
Besonderheiten: |
Dauer der Untersuchung: |
Klinik: |
Untersuchungsmaterial: |
Untersuchungsmethode(n): |
Besonderheiten: Der Antigen-Nachweis aus dem Serum dient der Früherkennung einer invasiven Aspergillose bei Risikopatienten. Der Antigennachweis aus Liquor dient der Diagnostik der zerebralen Aspergillose. Der Antigen-Nachweis aus BAL wird zur Diagnostik von pulmonalen Aspergillosen nach EORTC-Kriterien empfohlen Hinweis: Laut aktuellen Studien (z.B. JAC) und Kongressbeiträgen gibt es aktuell KEINE Einschränkung in der Befundung des Aspergillus-Antigens bei Pat. mit Piperacillin/Tazobactam Therapie. |
Dauer der Untersuchung: |
Klinik: |
Untersuchungsmaterial: |
Untersuchungsmethode(n): |
Besonderheiten: Eine PCR-Diagnostik auf atypische Mykobakterien ist nur sinnvoll bei mikroskopischem Nachweis von säurefesten Stäbchen im Untersuchungsmaterial, diese erfolgt in einem Speziallabor, nach Rücksprache mit dem Einsender. Für den kulturellen Erregernachweis aus Blut/Knochenmark keine EDTA-Zusätze verwenden. EDTA ist bakterizid! |
Dauer der Untersuchung: |
Klinik: |
Untersuchungsmaterial: |
Untersuchungsmethode(n): |
Besonderheiten: Die einzelnen Babesia species lassen sich mikroskopisch nicht unterscheiden. Hierfür wurden PCR-Methoden etabliert, die nur in Speziallaboratorien zur Verfügung stehen. In den USA ist die Babesiose auch serologisch nachweisbar. Eine Erregeranzucht ist nicht möglich. Epidemiologie: Vorkommen in USA, Europa. Seltene Erkrankung! |
Dauer der Untersuchung: |
Klinik: |
Untersuchungsmaterial: |
Untersuchungsmethode(n): |
Besonderheiten: |
Dauer der Untersuchung: |
Klinik: |
Untersuchungsmaterial: |
Untersuchungsmethode(n): |
Besonderheiten: Gezielter kultureller Erregernachweis aufgrund hartem klinischem Verdacht oder positiver Vorbefunde als externe Untersuchung |
Dauer der Untersuchung: |
Klinik: |
Untersuchungsmaterial: |
Untersuchungsmethode(n): |
Besonderheiten: Ein serologischer Nachweis von B. bacilliformis ist nicht verfügbar (Reiseanamnese!, Vorkommen in Peru, Ecuador, Kolumbien), der Nachweis kann mittels Blutausstrich und Giemsa-Färbung versucht werden. Molekularbiologische (PCR) und kulturelle Nachweismethoden stehen nur in Speziallaboratorien zur Verfügung. Des Weiteren kann in der Pathologie eine Warthin-Starry-Färbung an Gewebeschnitten durchgeführt werden. |
Dauer der Untersuchung: |
Klinik: |
Untersuchungsmaterial: |
Untersuchungsmethode(n): |
Besonderheiten: Zur Abklärung des Immunstatus gegenüber B.pertussis wird das Serum an ein auswärtiges Labor versandt. |
Dauer der Untersuchung: |
Klinik: |
Untersuchungsmaterial: |
Untersuchungsmethode(n): |
Besonderheiten: Bei V.a. Neuroborrelliose kann ein Serum/Liquor-Antikörper-Quotient bestimmt werden. Hierzu bitte parallel Serum und Liquor abnehmen, sowie je einen Teil der Probe in die Klinische Chemie zur |
Dauer der Untersuchung: |
Klinik: |
Untersuchungsmaterial: |
Untersuchungsmethode(n): |
Besonderheiten: |
Dauer der Untersuchung: |
Klinik: Das GBS-Screening dient zum sensitiven Nachweis der Kolonisierung zwischen der 35. und 37. SSW und erlaubt eine gute Vorhersage des Kolonisationsstatus unter der Geburt. |
Untersuchungsmaterial: |
Untersuchungsmethoden: |
Besonderheiten: Die Untersuchung wird nur zwischen der 35. und 37. SSW empfohlen. Gezielter Untersuchungsauftrag „B-Streptokokken-Screening“ erforderlich. |
Dauer der Untersuchung: |
Klinik: |
Untersuchungsmaterial: |
Untersuchungsmethode(n): |
Besonderheiten: |
Dauer der Untersuchung: |
Klinik: |
Untersuchungsmaterial: |
Untersuchungsmethode(n): |
Besonderheiten: Der Antikörpernachweis ist indiziert bei klinischem Hinweis auf Folgekrankheiten (Guillain-Barre-Syndrom, Arthritis) |
Dauer der Untersuchung: |
Klinik: |
Untersuchungsmaterial: |
Untersuchungsmethode(n): |
Besonderheiten: Der Nachweis von Candida spp. aus primär nicht sterilen Materialien (Trachealsekret, Sputum, Wunde) ist oft schwer zu interpretieren, da es bei hospitalisierten Patienten häufig zu einer klinisch wenig relevanten Besiedlung der Schleimhäute kommt. |
Dauer der Untersuchung: |
Klinik: |
Untersuchungsmaterial: |
Untersuchungsmethode(n): |
Besonderheiten: Bei unkomplizierten Infektionen des Urogenitaltraktes ist der PCR-Nachweis aus Erstrahlurin, Vaginal- bzw. Cervikal- oder Urethralabstrichen das Verfahren der Wahl. Bitte spezielles Abstrichbesteck benutzen! Bei V. a. chronische Infektionen des oberen Genitaltraktes und Folgeerkrankungen (Arthritis) den Antikörper-Nachweis von C. trachomatis anfordern. Bei V. a. Chlamydia pneumoniae und Chlamydia psittaci-Infektion Einsendung respiratorischer Untersuchungsmaterialien für den PCR-Nachweis. Bei V.a. Ornithose: PCR-Nachweis von C. psittaci aus respiratorischen Untersuchungsmaterialien (externe Untersuchung) |
Dauer der Untersuchung: |
Klinik: |
Untersuchungsmaterial: |
Untersuchungsmethode(n): |
Besonderheiten: Eine Untersuchung auf Clostridium botulinum wird nur auf Anforderung durchgeführt. Der Goldstandard zum Nachweis einer Intoxikation durch Clostridium botulinum erfolgt durch den Botulismustoxinnachweis im zuständigen Konsiliarlabor. Der Toxinnachweis aus Patientenserum gelingt beim Säuglings- und Wundbotulismus selten, ist bei der Lebensmittelintoxikation jedoch Mittel der 1. Wahl. Der Nachweis der übrigen Clostridium spp. wird durch die Untersuchungsanforderung "Erreger und Resistenz" gewährleistet. Bei Verdacht auf Wundgasbrand, dies bitte in den klinischen Angaben vermerken: Notfalluntersuchung! Generell gilt: Materialien, die auf strikte Anaerobier untersucht werden sollen, müssen entweder luftdicht verschlossen (z. B. in einer steril verschlossenen Spritze) oder aber in einem Anaerobier-geeigneten Transportmedium, z. B. Universalabstrich mit Amies-Transportmedium transportiert werden. |
Dauer der Untersuchung: |
Klinik: |
Untersuchungsmaterial: |
Untersuchungsmethode(n): |
Besonderheiten: |
Dauer der Untersuchung: |
Klinik: |
Untersuchungsmaterial: |
Untersuchungsmethode(n): |
Besonderheiten: |
Dauer der Untersuchung: |
Klinik: |
Untersuchungsmaterial: |
Untersuchungsmethode(n): |
Besonderheiten: Für den Schnellnachweis Crytococcus neoformans Antigen-Nachweis anfordern. |
Dauer der Untersuchung: |
Klinik: |
Untersuchungsmaterial: |
Untersuchungsmethode(n): Mikroskopie |
Besonderheiten: |
Dauer der Untersuchung: In Notfällen kann nach telefonischer Rücksprache eine zeitnahe Diagnostik z.B. Mikroskopie durchgeführt werden |
Klinik: |
Untersuchungsmaterial: |
Untersuchungsmethode(n): |
Besonderheiten: Da die Ausscheidung der Zysten unregelmäßig erfolgt, sind zur Diagnosestellung häufig wiederholte Stuhluntersuchungen nötig. |
Dauer der Untersuchung: |
Klinik: |
Untersuchungsmaterial: |
Untersuchungsmethode(n): |
Besonderheiten: Da die Ausscheidung der Zysten unregelmäßig erfolgt, sind zur Diagnosestellung häufig wiederholte Stuhluntersuchungen nötig. |
Dauer der Untersuchung: |

Klinik: |
Untersuchungsmaterial: |
Untersuchungsmethode(n): |
Besonderheiten: |
Dauer der Untersuchung: |
Klinik: |
Untersuchungsmaterial: |
Untersuchungsmethode(n): |
Besonderheiten: Aufgrund der hohen Infektiosität der angezüchteten Erreger, ist es dringend erforderlich, dass das Labor von dem einsendenden Arzt über die Verdachtsdiagnose "Infektion mit dimorphen Pilzen" informiert wird! |
Dauer der Untersuchung: |
Klinik: |
Untersuchungsmaterial: |
Untersuchungsmethode(n): PCR-Untersuchung auf Echinokokken-DNA (externe Untersuchung) |
Besonderheiten: |
Dauer der Untersuchung: |
Klinik: |
Untersuchungsmaterial: |
Untersuchungsmethode(n): Mikroskopie Antikörper-Nachweis (externe Untersuchung) |
Besonderheiten: |
Dauer der Untersuchung: |
Klinik: |
Untersuchungsmaterial: |
Untersuchungsmethode(n): |
Besonderheiten: Für das gezielte Screening auf multiresistente Erreger, siehe Abschnitt MRGN-Enterobakterien. |
Dauer der Untersuchung: |
Klinik: |
Untersuchungsmaterial: |
Untersuchungsmethode(n): |
Besonderheiten: |
Dauer der Untersuchung: |
Klinik: |
Untersuchungsmaterial: Vor allem Abstriche (gemäß Hygieneplan), Urin, sämtliche andere Abstriche, Körpersekrete, Punktate, Biopsien, Liquor, Blutkulturen, Fremdkörper etc. |
Untersuchungsmethode(n): |
Besonderheiten: Zum Nachweis von Carbapenemasen bei 4MRGN Enterobakterien steht eine multiplex PCR zur Verfügung. |
Dauer der Untersuchung: |
Klinik: |
Untersuchungsmaterial: |
Untersuchungsmethode(n): Mikroskopie |
Besonderheiten: Für die kulturelle Untersuchung auf Francisella tularensis muss eine gezielte Untersuchungsanforderung erfolgen. Um die notwendigen Sicherheitsvorkehrungen (L3-Organismus) und eine optimale Materialanlage zu gewährleisten, sollte der Probeneingang telefonisch angekündigt werden. Gezielter kultureller Erregernachweis aufgrund hartem klinischem Verdacht oder positiver serologischer Vorbefunde als externe Untersuchung |
Dauer der Untersuchung: Kulturelle Anzucht: mind. 2 Tage Erregeridentifizierung: ca. 2-3 Tage. |
Klinik: |
Untersuchungsmaterial: |
Untersuchungsmethode(n): |
Besonderheiten: |
Dauer der Untersuchung: |
Klinik: |
Untersuchungsmaterial: |
Untersuchungsmethode(n): Mikroskopie (Nachweis von Zysten bzw. Trophozoiten) |
Besonderheiten: Bei negativen Befund und anhaltendem Verdacht sollte Duodenalaspirat (nativ/Sediment) auf Lamblien untersucht werden. Duodenalaspirat für den Nachweis von Trophozoiten sollten in einem Zentrifugenröhrchen in einem Becher mit 37°C warmem Wasser transportiert werden. Die Proben sollten schnellstmöglich transportiert und untersucht werden. Eine Untersuchung von Material das älter als zwei Stunden ist, ist für den Nachweis vegetativer Formen in der Regel nicht sinnvoll |
Dauer der Untersuchung: |
Klinik: |
Untersuchungsmaterial: |
Untersuchungsmethode(n): |
Besonderheiten: Gonokokken sterben in der Umwelt sehr schnell ab und sind sehr kälteempfindlich. Daher ist der unverzügliche Transport der Probe ins Labor notwendig, wenn möglich stets auch den PCR-Nachweis anfordern. |
Dauer der Untersuchung: |
Klinik: |
Untersuchungsmaterial: |
Untersuchungsmethode(n): |
Besonderheiten: Die HACEK-Erreger gehören allesamt zur Normalflora der Mundhöhle bzw. des oberen Respirationstraktes des Menschen. Sie verursachen in der Regel opportunistische Infekte bzw. invasive Infektionen, wenn sie durch z. B. kleine Wunden im Mundbereich in den Blutkreislauf eingeschwemmt werden. |
Dauer der Untersuchung: |
Klinik: |
Untersuchungsmaterial: |
Untersuchungsmethode(n): Antigen-Nachweis |
Besonderheiten: Für spezielle Verdachtsfälle bei ambulant erworbenen Meningitisfällen (z.B. anhaltender Verdacht ohne kulturelles Wachstum) steht eine Multiplex-PCR auf die häufigsten Meningitis-Erreger zur Verfügung. Diese wird nur in Ergänzung der konventionellen Meningitis-Diagnostik (Mikroskopie+Kultur) und nach vorheriger Absprache mit dem Mikrobiologen durchgeführt. |
Dauer der Untersuchung: |
Klinik: |
Untersuchungsmaterial: |
Untersuchungsmethode(n): |
Besonderheiten: |
Dauer der Untersuchung: |
Klinik: |
Untersuchungsmaterial: |
Untersuchungsmethode(n): |
Besonderheiten: Indikation für den kultureller Erregernachweis: Resistenztestung nach Therapieversagen bzw. vor erstmaliger H. pylori Therapie bei Kindern. Biopsate in Portagerm pylori Transportmedium geben und die Proben möglichst schnell ins Labor transportieren, da die Erreger sehr empfindlich gegen Umwelteinflüsse sind. Indikation für den Antigen-Nachweis: Nicht-invasives Verfahren zur Kontrolle des Therapieerfolgs bzw. ergänzendes Verfahren zur Abklärung diskrepanter Vorbefunde. Achtung: Für eine zuverlässige Helicobacter pylori Diagnostik sollten folgende Mindestzeitintervalle ohne H. pylori suppressive Therapie eingehalten werden: 2 Wochen nach Ende einer Protonenpumpen-hemmer-Therapie und 4 Wochen nach vorangegangener Eradikationstherapie oder sonstiger Antibiotikatherapie. |
Dauer der Untersuchung: |
siehe Cystoisospora (vorher Isospora) belli
Klinik: Neben L. pneumophila als wichtigste humanpathogene Art werden L. bozemanii, L. dumoffii und L. micdadei als mäßig humanpathogen und L. anisa, L. ainthelensis, L. israelensis, L. birminghamensis, L. jordanis, L. oakridgensis, L. maceachernii, L. tusconensis, L. wadsworthii, L. feelei, L. gormanii, L. longbeachae und L. hackeliae als selten humanpathogen angesehen. Zahlreiche weitere Legionellen-Spezies kommen in der Umwelt vor und weisen nach heutigen Erkenntnissen keine Humanpathogenität auf. |
Untersuchungsmaterial: |
Untersuchungsmethode(n): |
Besonderheiten: Aus respiratorischen Sekreten wird in einer Multiplex-PCR sowohl Legionella spp. als auch eine spezifisch L. pneumophila (alle Serogruppen) erfasst. |
Dauer der Untersuchung: |
Klinik: |
Untersuchungsmaterial: |
Untersuchungsmethode(n): |
Besonderheiten: Der Antikörper-Nachweis erfolgt im Nationalen Referenzzentrum für tropische Infektionserreger. |
Dauer der Untersuchung: |
Klinik: |
Untersuchungsmaterial: |
Untersuchungsmethode(n): |
Besonderheiten: |
Dauer der Untersuchung: |
Klinik: |
Untersuchungsmaterial: |
Untersuchungsmethode(n): Multiplex-PCR aus Liquor |
Besonderheiten: Für spezielle Verdachtsfälle(z.B. anhaltender Meningitis-Verdacht ohne kulturelles Wachstum) bei ambulant erworbenen Meningitisfällen steht eine Multiplex-PCR auf die häufigsten Meningitis-Erreger zur Verfügung. Diese wird nur in Ergänzung der konventionellen Meningitis-Diagnostik (Mikroskopie+Kultur) und nach vorheriger Absprache mit dem Mikrobiologen durchgeführt. Die Untersuchung spezifischer Antikörper hat keine Aussagekraft und wird daher nicht empfohlen! |
Dauer der Untersuchung: |
Klinik: |
Untersuchungsmaterial: |
Untersuchungsmethode(n): Kultur Multiplex-PCR aus Liquor |
Besonderheiten: Für spezielle Verdachtsfälle(z.B. anhaltender Meningitis-Verdacht ohne kulturelles Wachstum) bei ambulant erworbenen Meningitisfällen steht eine Multiplex-PCR auf die häufigsten Meningitis-Erreger zur Verfügung. Diese wird nur in Ergänzung der konventionellen Meningitis-Diagnostik (Mikroskopie+Kultur) und nach vorheriger Absprache mit dem Mikrobiologen durchgeführt. |
Dauer der Untersuchung: |
Klinik: |
Untersuchungsmaterial: |
Untersuchungsmethode(n): |
Besonderheiten: Für die Untersuchung auf Mikrofilarien ist eine gezielte Untersuchungsanforderung notwendig, da Spezialfärbungen (Giemsa-Färbung) und eine Anreicherung der Erreger durchgeführt werden! Der Antikörper-Nachweis erfolgt im Nationalen Referenzzentrum für tropische Infektionserreger. |
Dauer der Untersuchung: |
Klinik: |
Untersuchungsmaterial: |
Untersuchungsmethode(n): |
Besonderheiten: |
|
Klinik: |
Untersuchungsmaterial: |
Untersuchungsmethode(n): |
Besonderheiten: |
Dauer der Untersuchung: |
Klinik: |
Untersuchungsmaterial: |
Untersuchungsmethode(n): |
Besonderheiten: Bei unbekanntem MRSA-Status für die Schnelldiagnostik den PCR-Nachweis anfordern. Geeignet für Intensivstationen und Kontaktpatienten. Ein positiver PCR-Nachweis sollte immer kulturell im Rahmen einer Abstrichrunde (Nase, Rachen, perianal, ggf. Wunde) bestätigt werden. Zum Screening vor Elektiveingriffen oder geplanten Aufnahmen wird der kulturelle Nachweis empfohlen. |
Dauer der Untersuchung: |
siehe Zygomyceten
Mycobacterium tuberculosis Komplex
Klinik: |
Untersuchungsmaterial: Sputum, Trachealsekret, Bronchialsekret, , Magennüchternsekret (in Natriumphosphat-Lösung, Transportröhrchen werden auf Anfrage den Stationen/Ambulanzen von der Abteilung zur Verfügung gestellt): ( 2-5 ml), Liquor (3-5 ml) Stuhl (indiziert bei immunsupprimierten Patienten bes. HIV-positiven Patienten), Urin (Morgenurin ≥ 30 ml) Vollblut (InTube-Plasma) mittels Vacutainer für den QuantiFERON®-Test. Es müssen 4 Röhrchen pro Patient eingehen! Röhrchen müssen genau bis zum schwarzen Strich (1 ml) befüllt sein! |
Untersuchungsmethode(n): Interferon-Gamma-Release-Assay: QuantiFERON®-TB (ELISA) |
Besonderheiten: Für den kulturellen Erregernachweis aus Blut/Knochenmark keine EDTA-Zusätze verwenden. EDTA ist bakterizid! Blut bzw. Knochenmark in Citrat oder Heparin einsenden. QuantiFERON®-Test: indirekter Test zum Nachweis einer M. tuberculosis-Infektion. Dieser Test stellt eine alternative zum Tuberkulin-Hauttest nach Mendel-Mantoux dar. Im Gegensatz dazu zeigt der QuantiFERON®-Test keine Kreuzreaktion mit dem Tuberkulose-Impfstamm (BCG). Ein positives Testergebnis kann nicht zwischen einer akut Behandlungsbedürftigen und einer latenten Tuberkulose unterscheiden. |
Dauer der Untersuchung: Mikroskopie: 4-5 Stunden |
siehe atypische Mykobakterien
Klinik: Mycoplasma pneumoniae: Atypische Pneumonie, Tracheobronchitis, Sinusitis, Pharyngitis |
Untersuchungsmaterial: M. pneumoniae: mind. 0,5 ml Respiratorische Sekrete (Rachenspülung, Gurgelwasser, Trachealsekret, Sputum, BAL etc.), Rachenabstrich, Serum |
Untersuchungsmethode(n): DNA-Nachweis (PCR) |
Besonderheiten: Bei Verdacht auf urogenitale Mykoplasmen erfolgt eine Multiplex-PCR auf urogenitale Mykoplasmen/Ureaplasmen, die M. hominis und M. genitalium erfasst. Eine Resistenztestung der Erreger ist bislang nicht möglich. |
Dauer der Untersuchung: |
siehe Gonokokken
siehe Meningokokken
Klinik: |
Untersuchungsmaterial: |
Untersuchungsmethode(n): |
Besonderheiten: |
Dauer der Untersuchung: |
Klinik: |
Untersuchungsmaterial: |
Untersuchungsmethode(n): |
Besonderheiten: |
Dauer der Untersuchung: |
Klinik: P. knowlesi |
Untersuchungsmaterial: |
Untersuchungsmethode(n): Antigen-Nachweis (Schnelltest) wird in der Regel bei jeder Untersuchung auf Malaria durchgeführt. |
Besonderheiten: Der Schnelltest erfasst vor allem Plasmodium falciparum und Plasmodium vivax. |
Dauer der Untersuchung: Mikroskopie: mehrere Stunden |
Klinik: |
Untersuchungsmaterial: |
Untersuchungsmethode(n): |
Besonderheiten: Sonstige Materialien: Der Nachweis von Plesiomonas spp. wird durch die Untersuchungsanforderung "Erreger und Resistenz" gewährleistet. |
Dauer der Untersuchung: Kultur: 2-4 Tage |
Klinik: |
Untersuchungsmaterial: |
Untersuchungsmethode(n): |
Besonderheiten: |
Dauer der Untersuchung: PCR: 1-4 Tage |
Klinik: |
Untersuchungsmaterial: |
Untersuchungsmethode(n): |
Besonderheiten: Zum Screening auf 3/4 MRGN Pseudomonaden bitte MRGN-Screening anfordern. |
Dauer der Untersuchung: |
siehe Zygomyzeten
Klinik: |
Untersuchungsmaterial: |
Untersuchungsmethode(n): |
Besonderheiten: Andere Materialien z.B. Blutkultur: Der Nachweis von Salmonella spp. wird durch die Untersuchungsanforderung „Erreger und Resistenz“ gewährleistet.
|
Dauer der Untersuchung: |
Klinik: |
Untersuchungsmaterial: |
Untersuchungsmethode(n): |
Besonderheiten: |
Dauer der Untersuchung: |
Klinik: |
Untersuchungsmaterial: |
Untersuchungsmethode(n): |
Besonderheiten: |
Dauer der Untersuchung: |
Klinik: S. epidermidis und sonstige Koagulase-negative Staphylokokken (KNS) wie S. hämolyticus, S. hominis: Endokarditis, Katheterinfektionen, sonstige Fremdkörperinfektionen |
Untersuchungsmaterial: |
Untersuchungsmethode(n): |
Besonderheiten: |
Dauer der Untersuchung: |
Klinik: |
Untersuchungsmaterial: |
Untersuchungsmethode(n): |
Besonderheiten: Für die Therapie ist Cotrimoxazol Mittel der Wahl. Nur für diese Substanz stehen derzeit Grenzwerte zur Beurteilung der MHK zur Verfügung. |
Dauer der Untersuchung: |




Klinik: |
Untersuchungsmaterial: |
Untersuchungsmethode(n): Ggf. Identifizierung mittels Sequenzierung des SodA-Gens |
Besonderheiten: Bei V. a. akute Pneumonie, Meningitis oder Sepsis steht ein Pneumokokken-Antigen-Nachweis aus Urin oder Für spezielle Verdachtsfälle(z.B. anhaltender Meningitis-Verdacht ohne kulturelles Wachstum) bei ambulant erworbenen Meningitisfällen steht eine Multiplex-PCR auf die häufigsten Meningitis-Erreger (inkl. S.pneumoniae und S.agalactiae) zur Verfügung. Diese wird nur in Ergänzung der konventionellen Meningitis-Diagnostik (Mikroskopie+Kultur) und nach vorheriger Absprache mit dem Mikrobiologen durchgeführt. |
Dauer der Untersuchung: Kultur:1-3 Tage |
siehe B-Streptokokken-Screening bei Schwangeren
Klinik: |
Untersuchungsmaterial: |
Untersuchungsmethode(n): |
Besonderheiten: |
Dauer der Untersuchung: |



Klinik: |
Untersuchungsmaterial: ggf. EDTA-Blut, Liquor, Fruchtwasser, Augenkammerflüssigkeit, Lymphknoten-Biopsien, Hirnbiopsien für den DNA-Nachweis |
Untersuchungsmethode(n): |
Besonderheiten: |
Dauer der Untersuchung: |

Klinik: |
Untersuchungsmaterial: |
Untersuchungsmethode(n): |
Besonderheiten: Bei V.a. Neurolues kann eine vergleichende Analyse von Serum und Liquor durchgeführt werden (externe Untersuchung). Hierzu bitte parallel Serum und Liquor abnehmen. |
Dauer der Untersuchung: |
Klinik: |
Untersuchungsmaterial: |
Untersuchungsmethode(n): |
Besonderheiten: |
Dauer der Untersuchung: |
Klinik: |
Untersuchungsmaterial: |
Untersuchungsmethode(n): |
Besonderheiten: |
Klinik: |
Untersuchungsmaterial: |
Untersuchungsmethode(n): Antikörper-Nachweis (externe Untersuchung) |
Besonderheiten: Für die Untersuchung auf Trypanosomen ist eine gezielte Untersuchungsanforderung notwendig, da Spezialfärbungen (Giemsa-Färbung) durchgeführt werden |
Dauer der Untersuchung: |
Klinik: |
Untersuchungsmaterial: Bei V. a. pulmonale Infektion bei Neugeborenen (≤ 6 Mon.): respiratorische Sekrete (für den DNA-Nachweis) |
Untersuchungsmethode(n): |
Besonderheiten: |
Dauer der Untersuchung: |
Klinik: |
Untersuchungsmaterial: |
Untersuchungsmethode(n): Resistenztestung |
Besonderheiten: |
Dauer der Untersuchung: |
Klinik: |
Untersuchungsmaterial: |
Untersuchungsmethode(n): Resistenztestung, Bestimmung des Resistenzgens mittels PCR (keine gesonderte Anforderung) |
Besonderheiten: |
Dauer der Untersuchung: |
Klinik: |
Untersuchungsmaterial: |
Untersuchungsmethode(n): |
Besonderheiten: Bei Verdacht auf Pest bitte unbedingt vorher telefonische Rücksprache mit dem Labor! Es handelt sich um einen Erreger dar Kategorie S3 (Gefahr von Laborinfektionen), außerdem müssen Spezialnährböden verwendet werden. Es sollte grundsätzlich ein gezielter Untersuchungsauftrag auf Yersinien erfolgen. |
Dauer der Untersuchung: |
Klinik: Zygomykose |
Untersuchungsmaterial: |
Untersuchungsmethode(n): |
Besonderheiten: Achtung: Voriconazol ist unwirksam. |
Dauer der Untersuchung: |
Leistungen
Die molekularbiologische Diagnostik stellt eine Ergänzung zur konventionellen kulturellen und serologischen Erregerdiagnostik dar.
Sie wird insbesondere zum Nachweis von Erregern durchgeführt, dienicht oder nur schwierig kulturell anzüchtbar sind
sehr langsam wachsen
Toxingene besitzen können, die mit einer sehr hohen Pathogenität verbunden sind (z. B. Corynebacterium diphtheriae)
Resistenzgene besitzen können, die von großer klinischer und klinikhygienischer Relevanz sind (z. B. Nachweis von MRSA)
Bei der molekularbiologischen Diagnostik wird die Nukleinsäure der jeweiligen Erreger, bzw. ein für den jeweiligen Erreger spezifisches Gen nachgewiesen. Dazu stehen verschiedene Methoden, wie z. B. die Polymerase-Ketten-Reaktion und der Einsatz von Sonden zur Verfügung. Da es sich bei den Methoden zum Nachweis von Nukleinsäuren um sehr empfindliche Verfahren handelt, die auch geringste Mengen Nukleinsäure des Erregers nachweisen können, müssen z. T. besondere Bedingungen bei der Materialentnahme und beim Transport beachtet werden:
Für den Nachweis von Chlamydien muss ein spezielles Abstrich-Set/Urin-Set benutzt werden ( erhältlich in der Apotheke des Klinikums). Da es sich bei
C. trachomatis um einen intrazellulären Erreger handelt, sollten möglichst zellreiche Abstriche gewonnen werden.Für den PCR-Nachweis von M. tuberculosis aus Liquor mind. 2-5 ml davon einsenden!
Auf saubere, kontaminationsfreie Materialentnahme achten.
Die molekularbiologische Diagnostik von Infektionserregern wird von unserem Labor grundsätzlich ein- bis zweimal pro Woche angeboten. Indikationen für die molekularbiologische Sofortdiagnostik müssen mit dem zuständigen Laborarzt für die Molekularbiologie unter den Aspekten Schwere des Krankheitsbildes sowie therapeutische bzw. klinikhygienische Konsequenzen abgesprochen werden.
Bitte beachten Sie, dass die Untersuchungsmethoden und das ausgewählte Spektrum der Erreger einer ständigen Aktualisierung unterliegen. Bei entsprechenden Fragen, auch hinsichtlich der Befundinterpretation, stehen Ihnen unsere Mitarbeiter und Mitarbeiterinnen der Molekularbiologie unter der Telefonnummer 65327 zur Verfügung. Über diese Nummer werden Sie auch an den zuständigen Laborarzt für die Molekularbiologie weitergeleitet.
Im Folgenden finden Sie eine Übersicht über die Erreger, die mittels Nukleinsäurenachweis nachgewiesen werden:
| Erreger | Untersuchungsmaterialien | Methode | Bemerkungen |
| Acanthamoeba spp. | Hornhautabrasio | Real-Time PCR | Bitte telefonische Rücksprache unter 65327. |
| Bordetella pertussis Bordetella parapertussis | Rachenabstrich, Trachealsekret, Bronchialsekret, BAL | Real-Time PCR | B. parapertussis nur nach telefonischer Rücksprache (65327) |
| Chlamydia pneumoniae | Rachenabstrich, Sputum, Trachealsekret, Bronchialsekret, BAL, Konjunktivalabstrich, Liquor | Real-Time PCR | |
| Chlamydia psittaci | Rachenabstrich, Sputum, Trachealsekret, Bronchialsekret, BAL, Konjunktivalabstrich, Liquor | Real-Time PCR | In der Regel nur indiziert bei anamnestischen Hinweis auf Vogelkontakt. |
| Chlamydia trachomatis | Rachenabstrich, Trachealsekret, Bronchialsekret, BAL | Real-Time PCR | Achtung! Nur bei klinischem Verdacht auf Neugeborenen-Pneumonie indiziert (Neugeborene und Säuglinge < 6 Monate) Material sofort in Transportmedium (BD Molecular Swab Collection Kit) überführen! |
| Chlamydia trachomatis | Konjunktivalabstrich, Urethralabstrich, Zervikalabstrich, Vaginalabstrich, Erststrahlurin | Real-Time PCR | Material sofort in Transportmedium überführen! Abstriche: BD Molecular Swab Collection Kit |
| Gastroenterits-Erreger (Campylobacter, Salmonella, Shigella, EHEC, Yersinia etc.) | Stuhl | Multiplex-PCR | Bei Eingang im Labor bis 11Uhr erfolgt die Untersuchung am selben Tag. |
| Legionella pneumophila | Rachenabstrich, Trachealsekret, Bronchialsekret, BAL | Real-Time PCR | Es wird zusätzlich eine PCR durchgeführt, die alle Legionella-Arten nachweist. |
| Methicillin-resistenter S. aureus (MRSA) | Nasenabstrich, Wundabstrich | Real-time PCR | Die PCR wird zum MRSA-Screening empfohlen. |
| Mycobacterium tuberculosis | Trachealsekret, Bronchialsekret, BAL, induziertes Sputum, Liquor (mind. 2-5 ml), Punktate und Biopsien (nach telefonischer Rücksprache) | Real-Time PCR | Die PCR ist nur für Materialien des Respirationstraktes standardisiert. |
| Mycoplasma pneumoniae | Rachenabstrich, Trachealsekret, Bronchialsekret, BAL | Real-Time PCR | |
| Neisseria gonorrhoeae | Urethralabstrich, Zervikalabstrich, Erststrahlurin | Real-Time PCR | Material sofort in Transportmedium überführen! |
| Trichomonas vaginalis | Urethralabstrich, Zervikalabstrich, Erststrahlurin | Real-Time PCR | Material sofort in Transportmedium überführen! |
| Toxoplasma gondii | Liquor | PCR | Auswärtige Untersuchung |
| Ureaplasma urealyticum | Rachenabstrich, Trachealsekret, Bronchialsekret, BAL | Real-Time PCR | nur bei Neugeborenen und Säuglingen < 6 Monate! |
| eubakterielle PCR (erfasst alle relevanten pathogenen Bakterien) | primär sterile Materialien (Liquor, Biopsien, etc.) | PCR anschließende Sequenzierung* | nur nach telefonischer Rücksprache unter 65327. |
| Meningitis-Multiplex-PCR | Liquor | Multiplex-PCR | nur nach telefonischer Rücksprache unter 65327. |
Neben den in der Tabelle aufgeführten Nukleinsäurenachweisen stehen Untersuchungen für die Kulturbestätigung bzw. den Toxinnachweis bestimmter Erreger zur Verfügung, die im Rahmen der jeweiligen Erregerdiagnostik eingesetzt werden:
- Corynebacterium diphtheriae Toxin-Gen (Real-Time PCR)
- Escherichia coli (EHEC) (Real-Timer PCR)
- Nicht. tuberkulöse Mykobakterien (NTM) (mit Genotype)
- Mycobacterium tuberculosis Komplex (mit Genotype)
- Vancomycin-resistente Enterokokken (VRE) (Real-Time PCR)
- Burkholderia cepacia Genomovar I, IIIA (BlockCycler PCR)
- Burkholderia multivorans (BlockCycler PCR)
- Carbapenemase-PCR (Multiplex-PCR)
- LukS-Gen (Panton-Valentine-Leukozidin in S. aureus) (Real-Time PCR)
- Oxa-23-Gen in Acinetobacter baumanii (Real-Time PCR)
Neben der oben beschriebenen Nukleinsäurediagnostik ist es möglich, biochemisch nicht eindeutig zu bestimmende Erreger (Bakterien und Pilze) mittels Gen-Sequenzierung* molekularbiologisch zu identifizieren. Da es sich hierbei um eine sehr zeit- und kostenintensive Spezialdiagnostik handelt, wird eine Sequenzierung nur bei einem signifikanten Keimnachweis und nach Rücksprache mit dem einsendenden Arzt bezüglich der klinischen Relevanz des Erregernachweises durchgeführt.
* Die Sequenzierung wird als Teilschritt der Identifizierung im Unterauftrag an ein für dieses Verfahren akkreditiertes Speziallabor vergeben.
In der Infektionsserologie handelt es sich stets um spezielle Anforderungen zum Nachweis von Antigen oder Antikörpern gegen bestimmte Erreger. Eine Ausnahme hiervon stellt nur die Anforderung Arthritisserologie dar, bei der Antikörper gegen eine bestimmte Auswahl von Infektionserregern, die eine Arthritis induzieren können, untersucht werden.
Welche Untersuchungen werden angeboten?
Die Antigen- und Antikörper-Nachweis umfassen die in der nachfolgenden Tabelle genannten bakteriellen und parasitären Infektionserreger sowie pathogene Pilze. Zusätzlich können Spezialuntersuchungen (nur bei stationären Patienten) durchgeführt werden, die an auswärtige Laboratorien, z. B. das Bernhard-Nocht-Institut für Tropenmedizin, weitergeleitet werden. Bei den auswärtigen Laboratorien handelt es sich ausschließlich um Nationale Referenzzentren oder Speziallaboratorien mit einem hohen Qualitätsstandard. Bei Anforderungen, die nicht auf dem Anforderungsschein erwähnt sind, setzen Sie sich bitte vor Einsendung der Probe mit der Infektionsserologie in Verbindung (Tel. 65327 / 65376).
Welches Untersuchungsmaterial ist geeignet?
Bei den allermeisten Untersuchungen ist das geeignete Untersuchungsmaterial Serum. Dafür sollten nicht weniger als 2 ml Venenblut unter Vermeidung von Hämolyse und ohne Zusatz von gerinnungshemmenden Substanzen in einer Serummonovette in das Institut für Medizinische Mikrobiologie und Hygiene eingeschickt werden. Bei klinischem Verdacht auf eine akute Infektion ist stets die Einsendung einer gepaarten Serumprobe ca. 2-4 Wochen nach der Erstuntersuchung sinnvoll. Dadurch können Titerbewegungen oder Antikörper-Konversionen erfasst werden. Bei einigen wenigen Indikationen (z. B. V. a. Neuro-Borreliose, V. a. Neuro-Syphilis) ist die Einsendung von einer gepaarten Probe Serum und Liquor sinnvoll. In diesem Falle muss stets auch eine Bestimmung von Gesamt-IgG und Albumin in Serum und Liquor in der klinischen Chemie erfolgen, damit ein spezifischer Serum/Liquor-Antikörper-Quotient errechnet werden kann! Nur dieser kann eine Infektion des Zentralnervensystems mit hoher Wahrscheinlichkeit belegen.
Wie oft werden die Untersuchungen durchgeführt?
Die Untersuchungen werden in Abhängigkeit des Probenaufkommens mindestens einmal wöchentlich durchgeführt. Untersuchungsmaterialien, bei denen der Nachweis von Aspergillus-Antigen oder Kryptokokken-Antigen angefordert ist, werden arbeits- bzw. werktäglich bearbeitet.
Wie kann ich das infektionsserologische Labor erreichen?
Bitte beachten Sie, dass die Untersuchungsmethoden und das ausgewählte Spektrum der Erreger einer ständigen Aktualisierung unterliegen. Bei entsprechenden Fragen, auch hinsichtlich der Befundinterpretation, stehen Ihnen unsere Mitarbeiter und Mitarbeiterinnen der Infektionsserologie unter der Telefonnummer 65327 / 65376 zur Verfügung. Über diese Nummer werden Sie auch an den zuständigen Laborarzt für die Infektionsserologie weitergeleitet.
| Erreger | Untersuchungs-materialien | Methode | Bemerkungen |
| Aspergillus spp. | Serum | Antigennachweis mittels ELISA | Der Antigennachweis ist bei Verdacht auf eine invasive systemische Aspergillose indiziert. |
| Bartonella henselae Bartonella quintana | Serum | Antikörper-Nachweis mittels Mikroimmunfluoreszenztest | |
| Bordetella pertussis | Serum |
Antikörper-Nachweis mittels | Indikation
|
| Borrelia burgdorferi | Serum Liquor | Antikörper-Nachweis mittels:
|
Suchtest |
| Brucella spp. | Serum | IgG-/IgM ELISA | |
| Campylobacter jejuni Campylobacter coli | Serum | Antikörper-Nachweis mittels | |
| C. trachomatis | Serum | Antikörper-Nachweis mittels | * Indikation: Tubarsterilität, aufsteigende Infektion, reaktive Arthritis
Nukleinsäurenachweis siehe "Molekularbiologie" |
| C. pneumoniae | bronchoalveoläre Lavage | Erregeranzucht mittels Zellkultur;(nur nach Rücksprache in Ausnahmefällen) | Das Chlamydien-Transportmedium für die Kultur kann unter 65327 bestellt werden.
Nukleinsäurenachweis siehe "Molekularbiologie" |
| Coxiella burnetii (Q-Fieber) | Serum | Antikörper-Nachweis mittels Mikroimmunfluoreszenztest | |
| Cryptococcus neoformans | Serum Liquor | Antigen-Nachweis mittels Agglutinationsreaktion | |
| Echinococcus spp. E. multilocularis | Serum | Antikörper-Nachweis mittels ELISA | Suchtest und Speziesdifferenzierung |
| Legionella spp. | Urin | Antigennachweis mittels Schnelltest |
Nukleinsäurenachweis aus respiratorischem Material siehe "Molekularbiologie" |
| Leptospiren | Serum | Antikörper-Nachweis mittels IgM-ELISA | Ab dem 6. bis 10. Krankheitstag treten spezifische Ak auf. |
| Mycoplasma pneumoniae | Serum | Antikörper-Nachweis mittels ELISA |
Nukleinsäurenachweis aus respiratorischem Material siehe "Molekularbiologie" |
| Streptococcus pneumoniae | Urin | Antigennachweis mittels Schnelltest | nicht für Kinder <6Jahre geeignet |
| Toxopolasma gondii | Serum | Antikörper-Nachweis mittels: IgG-,IgM-ELFA Immunoblot IIFT |
Suchtest |
| Treponema pallidum (Lues) | Serum Liquor* | Antikörper-Nachweis mittels: |
Suchtest |
Yersinia spp. Yersinia pseudotuberculosis | Serum | Antikörper-Nachweis mittels IgA-Immunoblot | Indiziert vor allem bei nichtenteritischer, intestinaler (pseudoappendizitischer) und extraintestinaler Yersiniose. |
Abkürzungen:
Ag | Antigen |
Ak | Antikörper |
ELISA | Enzyme linked immuno assay |
ELFA | Enzyme-linked flourescent assay |
FTA-Abs | Fluoreszenz Treponema Anitkörper- Absorptionstest |
IIFT | indirekter Immunfluoreszenztest |
PCR | Polymerase chain reaction |
Downloads
- Anforderungsschein Mikrobiologie (Bakteriologie, Mykobakteriologie, Mykologie und Parasiten) (PDF, 377 KB)
- Anforderungsschein Serologie und Molekularbiologie (PDF, 74 KB)
- Übersicht Lagerungsbedingungen (PDF, 132 KB)
- Leistungsverzeichnis nach Diagnosen (PDF, 2 MB)
- Leistungsverzeichnis nach Erreger (PDF, 1 MB)
- Leistungsverzeichnis nach Material (PDF, 2 MB)
- Auflistung der Probengefäße (PDF, 219 KB)
Antibiotic Stewardship (ABS)
Dateien zum Download (nur intern verfügbar)
Anregungen / Lob / Beschwerde
Sie haben die Möglichkeit über unser Onlineformular Rückfragen, Beschwerden oder auch Lob an unser Labor zu richten.
Nach Eingang Ihrer Anfrage werden wird den geeigneten Ansprechpartner finden, der sich mit der Bearbeitung des Sachverhaltes beschäftigen wird. Die Bearbeitung wird unabhängig und unparteilich erfolgen.
Bitte haben Sie dafür Verständnis, dass die Bearbeitung mehrere Wochen dauern kann.